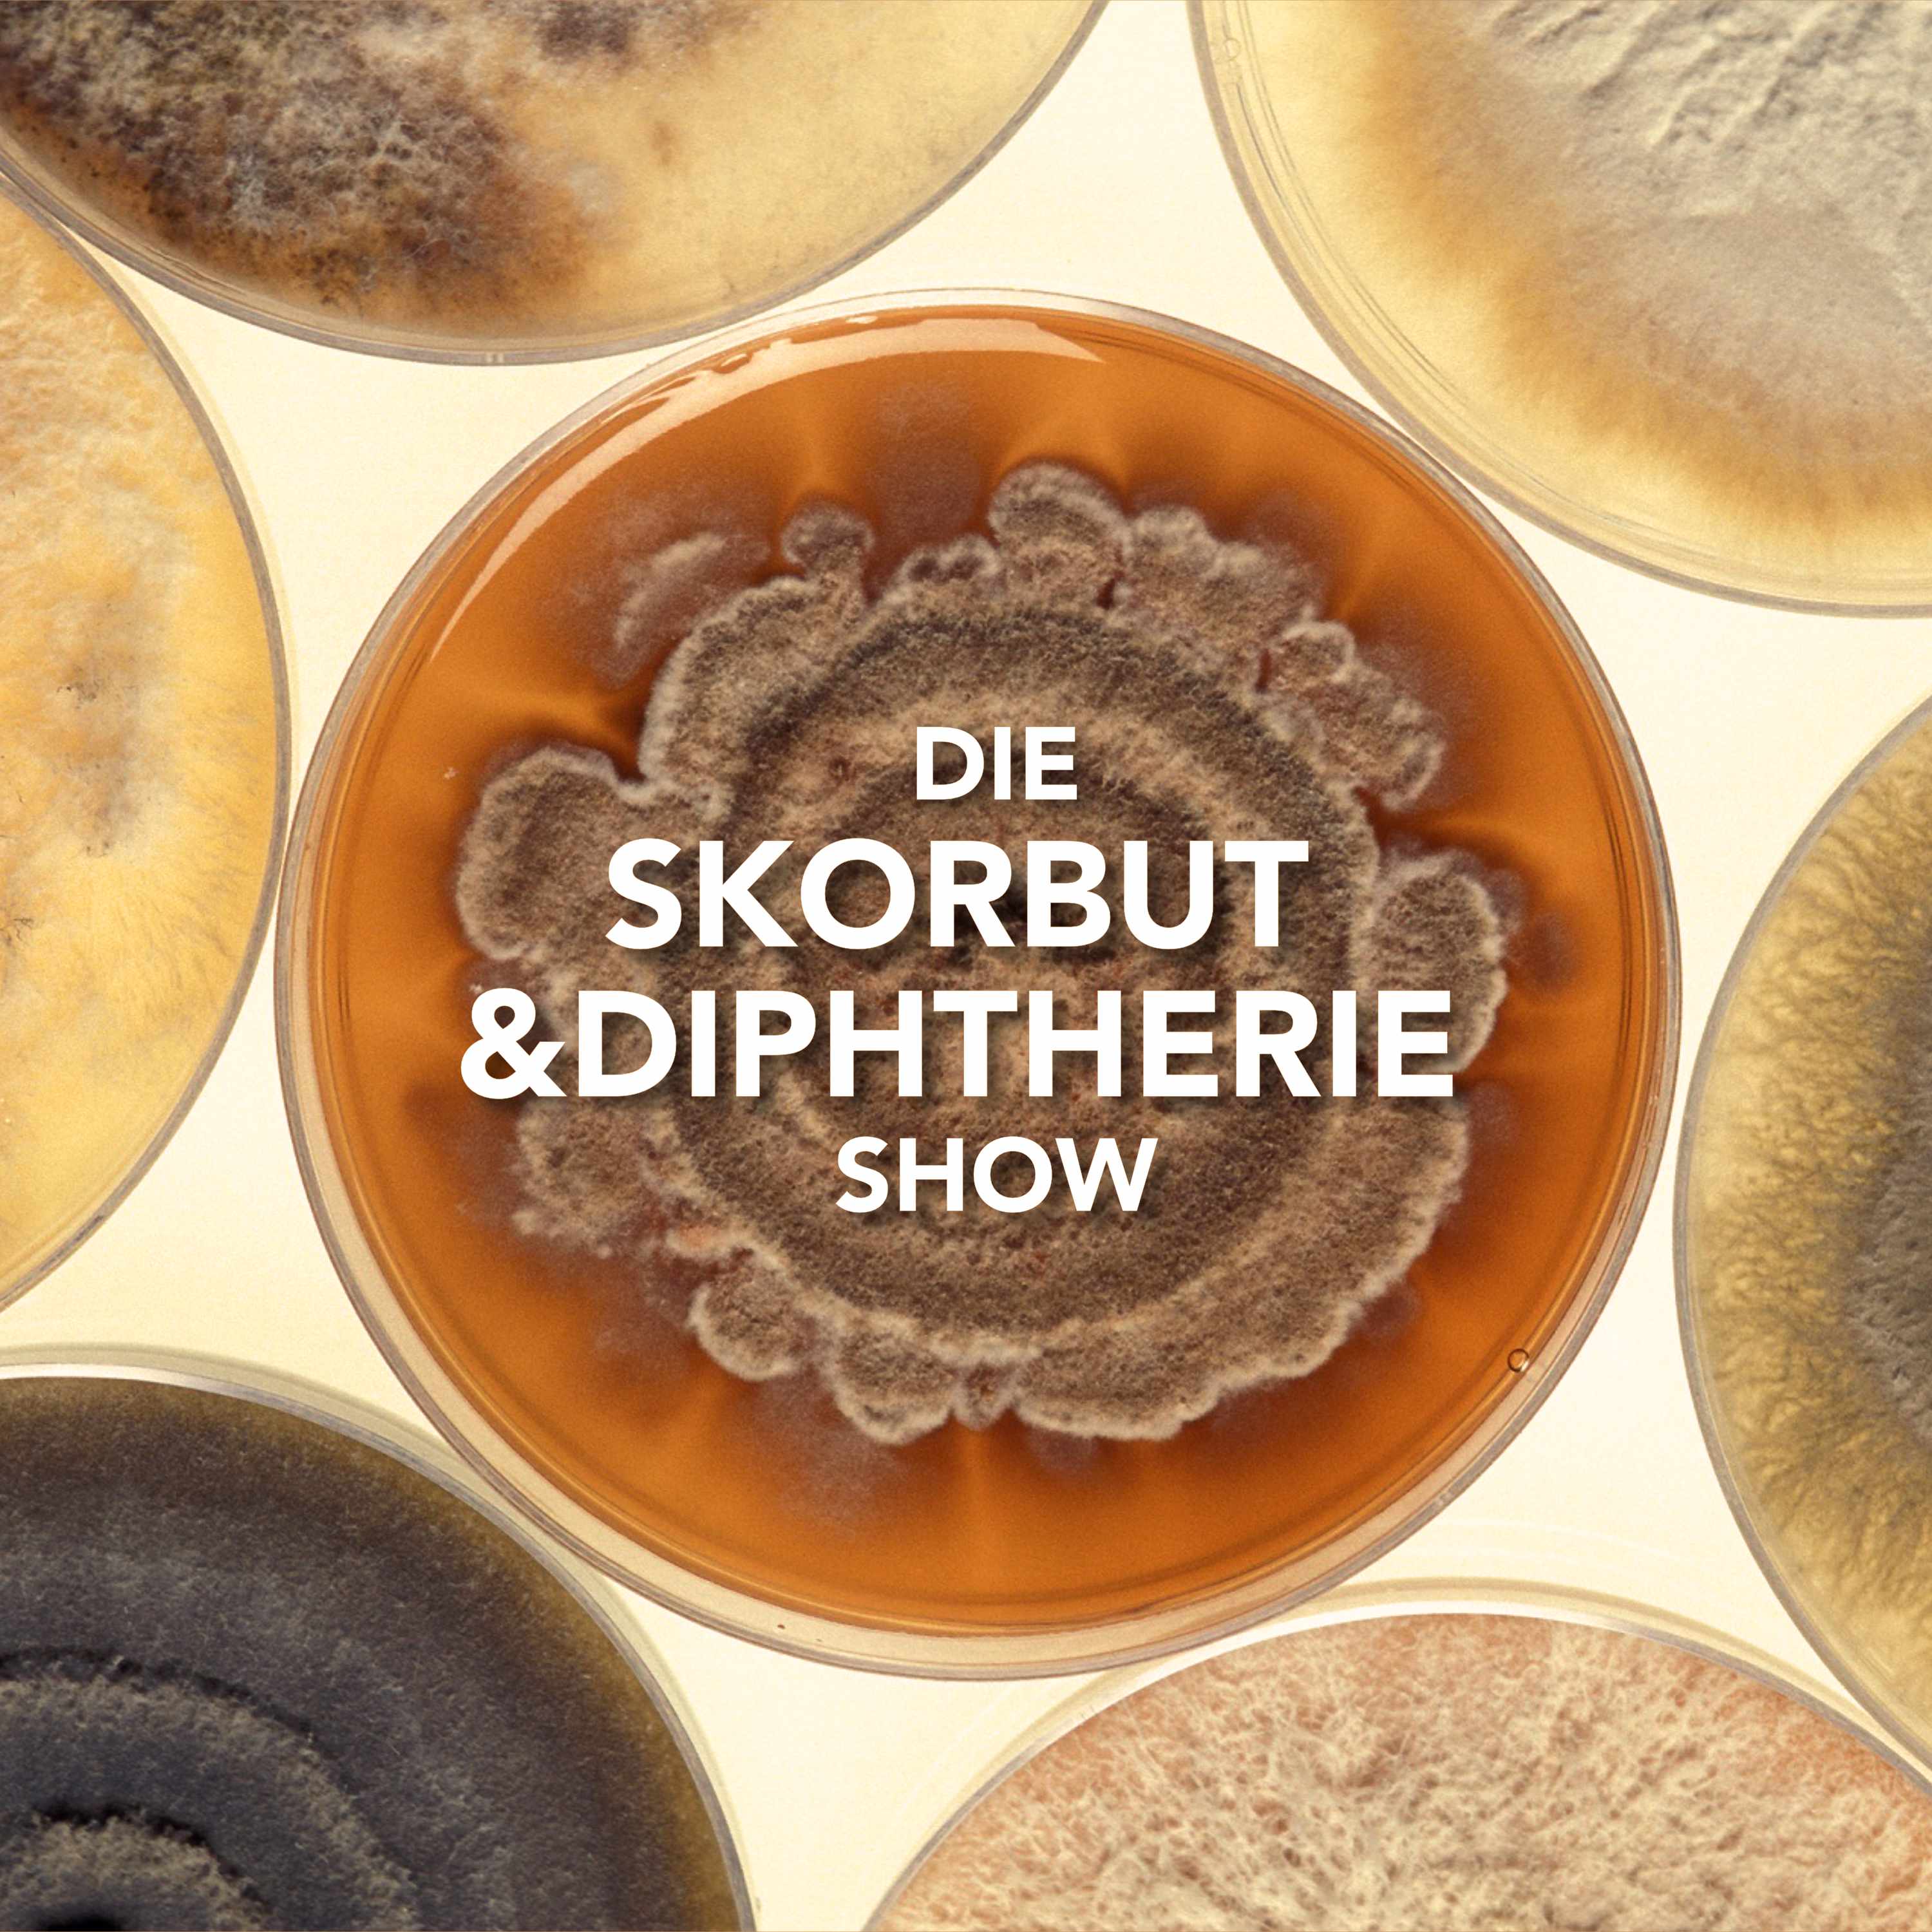
Die Skorpion und Batterie Show | Die On-Demand Late-Night-Show aus Berlin!
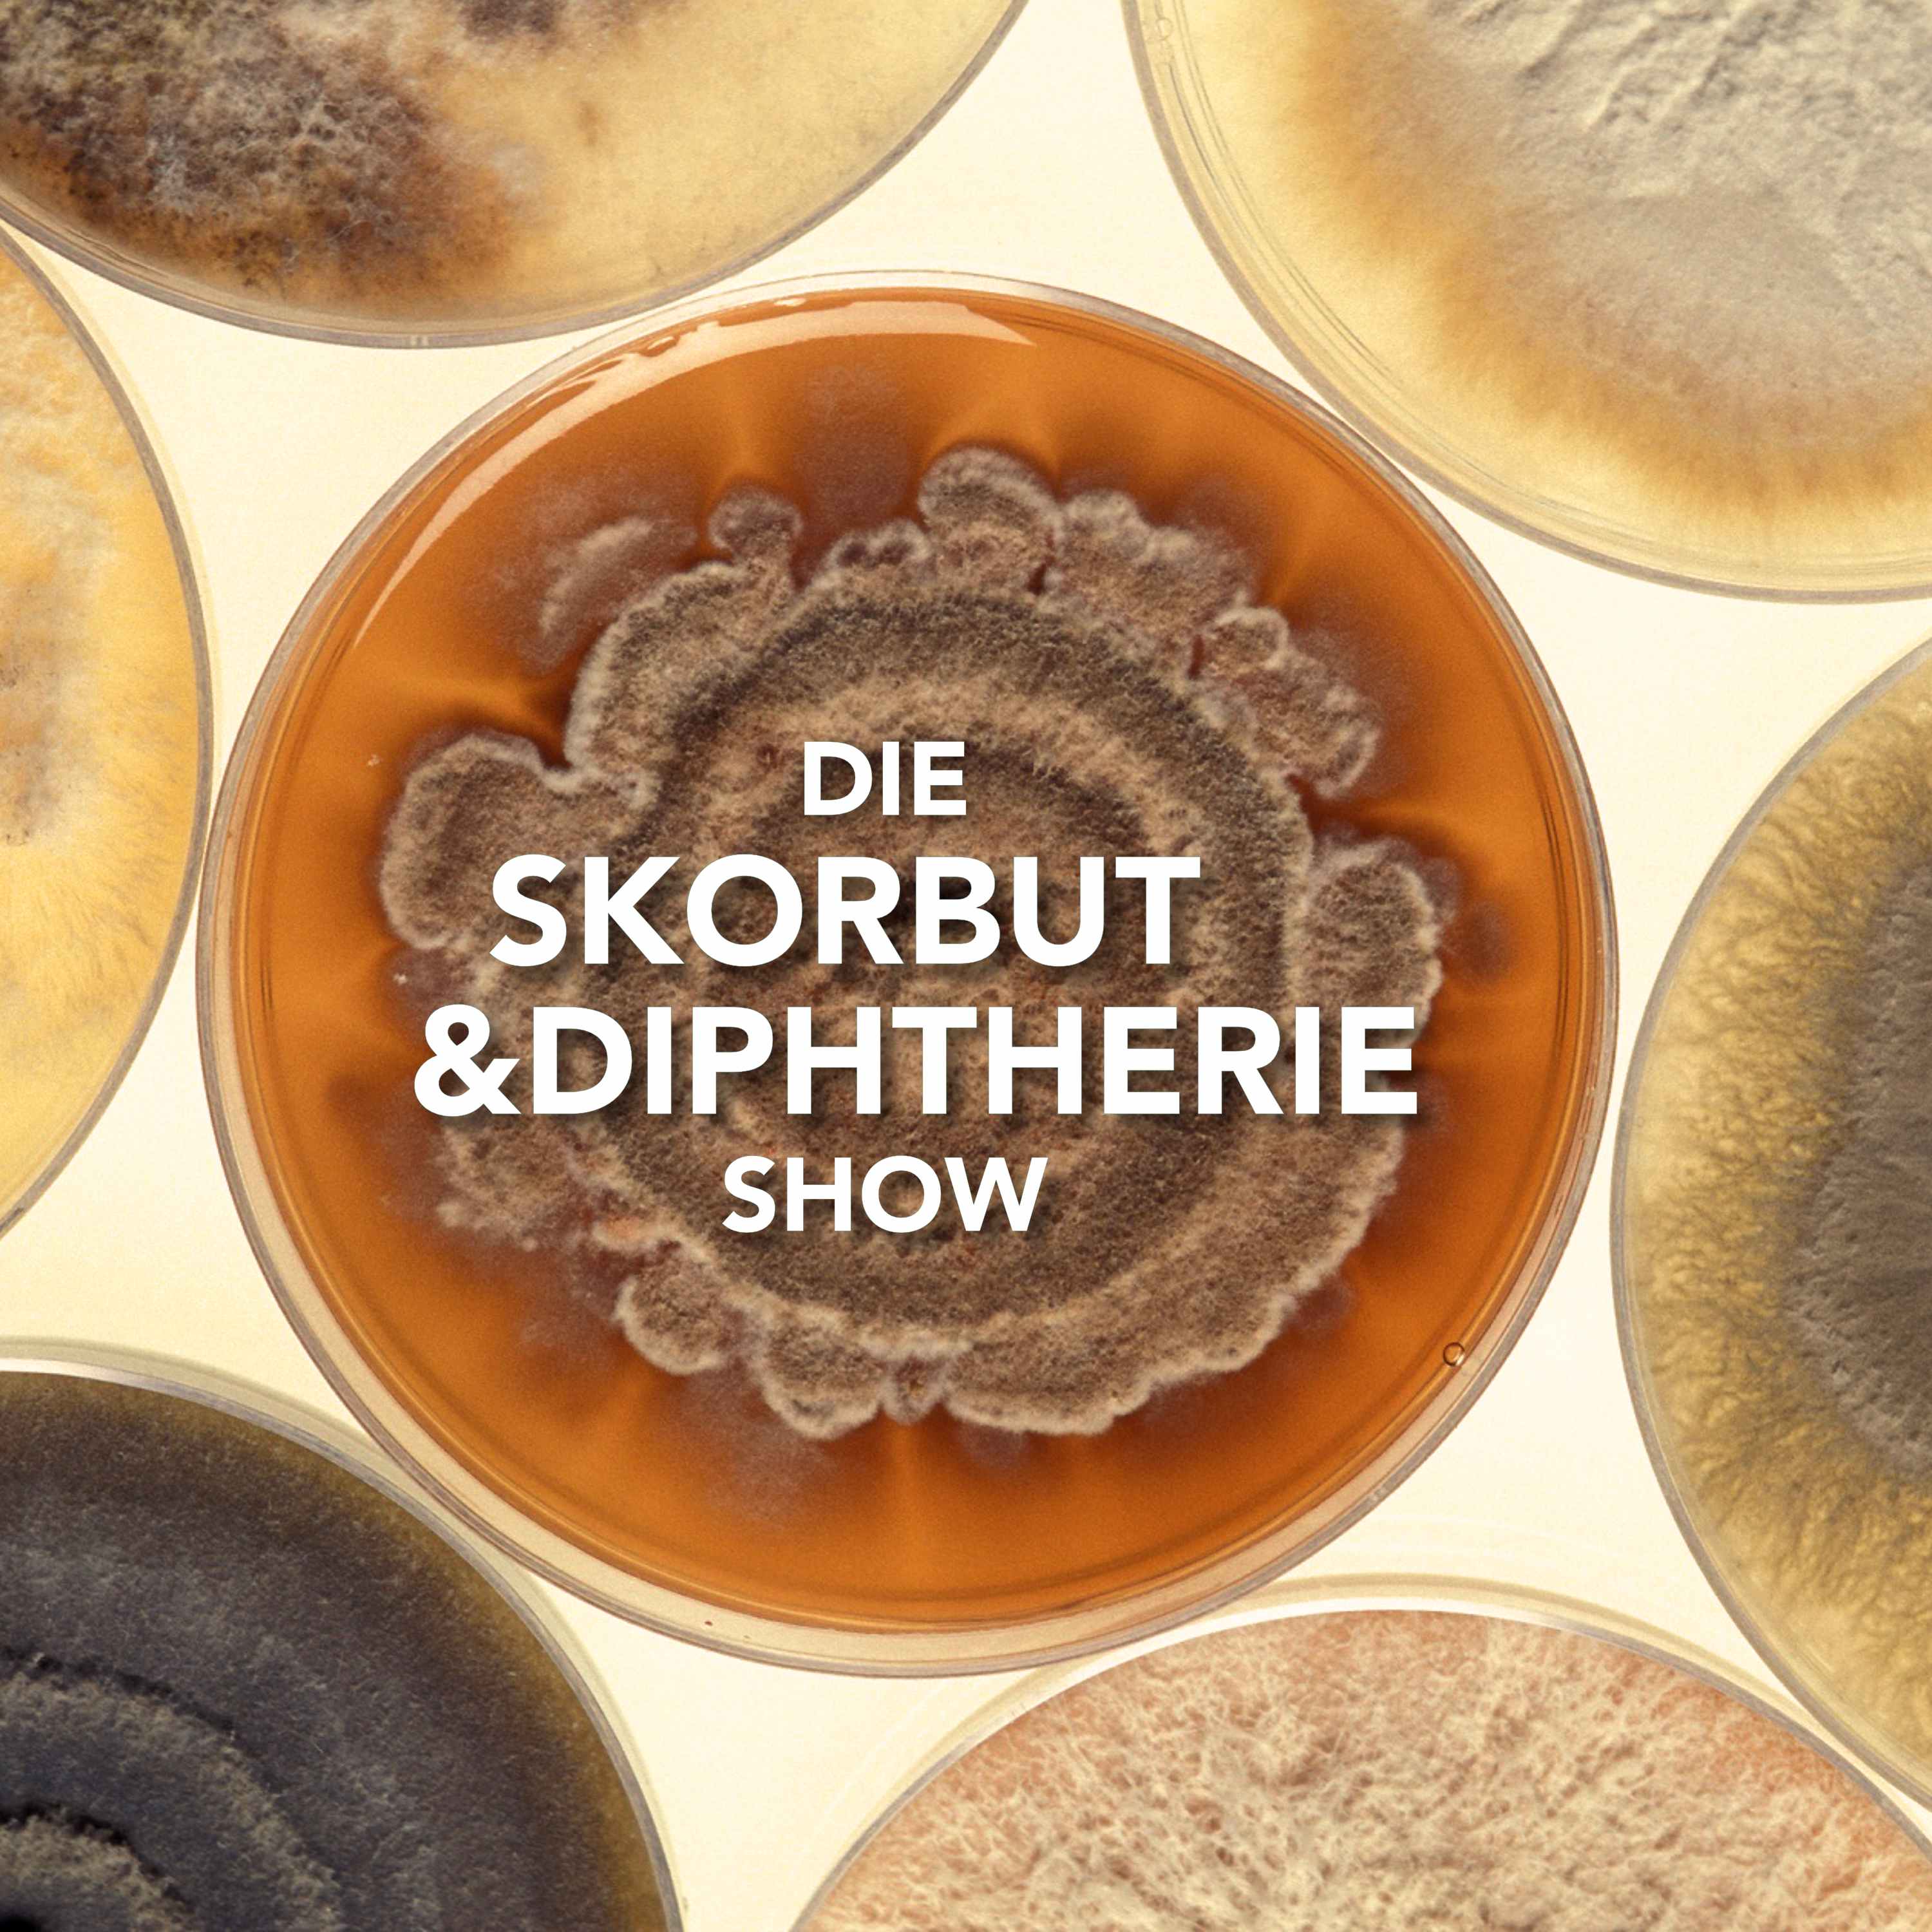
Die Skorpion und Batterie Show | Die On-Demand Late-Night-Show aus Berlin!

Shows

Die Skorpion und Batterie Show | Die On-Demand Late-Night-Show aus Berlin!Zwischen Spitzenschuh und Khlav KalashDiese Ausgabe der Skorpion und Batterie Show meldet sich direkt von der Grünen Woche in Berlin. Zwischen Probierständen, Landmaschinen und Hauptstadttrubel berichtet Commodore Schmidlabb live vom Messegeschehen – mit hungrigem Magen und offenem Mikrofon.
Doch es bleibt nicht bei einem Blick in die Genußlandschaft: Der Commodore stellt außerdem ein außergewöhnliches Wissenschaftsmagazin vor, das komplexe Themen klug, verständlich und unterhaltsam vermittelt – eine echte Empfehlung für alle, die in der Mediathek von ARTE zuhause sind.
Und dann wäre da noch sein möglicher Seitenwechsel auf die Bühne: Commodore Schmidlabb beri...
2026-02-1800 min
Die Skorpion und Batterie Show | Die On-Demand Late-Night-Show aus Berlin!Die Bibliothek der guten LauneFrisch aus der Bibliothek der guten Laune: die neue Folge der Skorpion und Batterie Show 🦂⚡️!
In der Medienecke haben wir für euch eine Dokumentation über einen mittelalterlichen "Zwergstaat" in Texas eingestellt. In der Abteilung "Nutzloses Partywissen" erfahrt ihr alles über eine viktorianische Kampfsport-Art. Und zusammen mit seiner Kollegin Britt-Marie hat Commodore Schmidlabb das Hörbuch-Regal gut gefüllt. Mit dabei Gender-Studies, cosy Fantasy, Rock'n Roll Lifestyle, griechische Sagen und mehr.
Aber Vorsicht: Wer den Podcast nicht innerhalb der Leihfrist von 14 Tagen zurückgibt, muss eine Strafgebühr zahlen!
-----------
Feedback an:
2025-06-271h 33
Die Skorpion und Batterie Show | Die On-Demand Late-Night-Show aus Berlin!Kinderdetektivin Elena ermittelt!In dieser Folge der Skorpion und Batterie Show wird es kriminell gemütlich! Commodore Schmidlabb hat auf dem Sofa einer lieben Freundin Platz genommen und mit ihr entdeckt, wie man dem kalten Winter ab besten entkommen kann – Mit einen (mehr oder weniger) guten Buch! Zusammen lesen sie die erste Ausgabe der legendären Nancy-Drew-Reihe: „Mord steht nicht auf dem Stundenplan“.
Doch damit nicht genug: Die beiden versuchen, den Täter oder die Täterin zu erraten – live und in Echtzeit! Und das Beste daran? Ihr könnt mitraten! Wer ein Herz für Kinderdetektive hat, seien es die drei Frage...
2025-04-213h 23
Die Skorpion und Batterie Show | Die On-Demand Late-Night-Show aus Berlin!Make Death sexy again!Diese Episode zeigt eindrucksvoll, wie Büchereien Leben verändern können. Hätte Commodore Schmidlabb in seiner Kleinstadt-Bibliothek nicht zufällig eine CD von PJ Harvey ausgeliehen, wäre diese Folge nie entstanden. Wenn es um die Musik des Chamäleons aus dem beschaulichen Dorset geht, wird er zum leidenschaftlichen Missionar. Zu Beginn der Episode gibt Schmidlabb daher einen umfassenden Überblick über PJ Harveys Werk.
Wer diesen intensiven Fangirl-Test übersteht, wird in der Rubrik "Nutzloses Partywissen" mit einem faszinierenden Einblick in die Geschichte der "aufgeschlitzten Schönheiten" belohnt – anatomische Wachsmodelle, die den Tod wieder sexy machen sollten.
...
2025-02-0255 min
Die Skorpion und Batterie Show | Die On-Demand Late-Night-Show aus Berlin!Füße geblutet!Diesmal ruft Commodore Schmidlabb das Abenteuer! Doch was zählt in seinem Alter noch als Abenteuer? Für Freeclimbing ist er nicht schwindelfrei genug und für eine Weltumrundung im Wohnmobil fehlt ihm... eigentlich Alles.
Doch warum überhaupt in die Ferne schweifen? Das Abenteuer liegt bekannterweise vor der Haustür. Also macht sich der olle Schmidlabb mit seinem Freund Björn auf den Weg, ein kleines Abenteuer mitten durch Berlin zu erleben. Zusammen haben sie sich nämlich vorgenommen, den kompletten Verlauf der Spree durch die Hauptstadt entlang zu wandern.
Wir verraten natürlich nicht, ob sie e...
2024-11-061h 32
Die Skorpion und Batterie Show | Die On-Demand Late-Night-Show aus Berlin!Hausverbot in der StaatsoperHier geht es zur Umfrage zur Folge! https://fragab.de/Vh9Z1ejc
Es wird ernst! In dieser brandneuen Folge seines Late-Night-Show-Podcasts lädt euch Commodore Schmidlabb höchstpersönlich zum Tanz ein. Gemeinsam mit seinem Tanzpartner Christian taucht er tief in die aktuellen Programme der Ballettkompanien ein und bietet euch sogar die Gelegenheit, sich live und in Farbe zu treffen, um gemeinsam eine beeindruckende Tanzvorführung zu erleben.
Doch damit nicht genug: In der beliebten Rubrik „Nutzloses Partywissen“ entführt euch der Commodore in die mysteriöse Welt der Phantominseln – ein Thema, das euch garantiert b...
2024-08-161h 42
Die Skorpion und Batterie Show | Die On-Demand Late-Night-Show aus Berlin!Kleinparteien zum EuropawahlkrampfDer Wahlzettel zur Europawahl scheint gefühlt wieder einen halben Meter länger geworden zu sein. Damit ihr den Überblick über die immer vielfältiger werdende Parteienlandschaft nicht verliert, hat sich Commodore Schmidlabb den Lokalpolitiker und allseits beliebten Supertypen American Cyborg Terminator 2K zur Hilfe geholt. Gemeinsam nehmen sie euch mit auf eine unterhaltsame Reise durch die Institutionen der EU und stellen euch vier Kleinparteien vor, die jeweils sehr unterschiedliche Visionen für unseren Kontinent haben.
In dieser Ausgabe unseres Polit-Magazins der nächsten Generation: die Partei des Fortschritts, die Aktion Bürger für Gerechtigkeit, die Partei de...
2024-05-222h 17
Die Skorpion und Batterie Show | Die On-Demand Late-Night-Show aus Berlin!Der erste Podcast aus Marzipan!Fast fünf Jahre lang hat ein Team von Wissenschaftlerinnen und Wissenschaftlern aus Nordkorea, Italien und von der Isle of Man versucht, einen Podcast aus Marzipan herzustellen. Jetzt ist es Ihnen endlich gelungen und Commodore Schmidlabb freut sich sagen zu können, dass ausgerechnet die erste Weihnachtsfolge der Skorpion und Batterie Show als Testsubjekt auserkoren wurde.
Da die Verkostung des ersten Podcasts aus Marzipan ein Ereignis von Weltrang ist, hat sich der Commodore gleich zwei Gäste zum Geschmackstest eingeladen. Zusammen feiern sie ein (einigermaßen) ostdeutsches Weihnachtsfest. Traditionell gehört dazu das Erzählen von Geschichten darüber...
2023-12-201h 41
Im Gehörgang Ihrer Majestät | Der James Bond PodcastSondersendung: Octopussy im Visier der Spionageabwehr mit Helmut Müller-EnbergsOctopussy, Rogers Moores vorletzter Auftritt als James Bond, wird 2023 satte vierzig Jahre alt. Grund genug, mal mit anderen Augen auf den Film zu schauen. Daher haben wir das Agenten-Abenteuer dem Geheimdienst-Experten Helmut Müller-Enbergs vorgelegt, der weiß, wie die Spionagelandschaft des Jahres 1983 wirklich ausgesehen hat. Der Politikwissenschaftler, Stasi-Experte und ehemalige Leiter der Spionageabwehr des Berliner Verfassungsschutzes erklärt uns, wo Octopussy erstaunlich nah an der Realität war und wo der Film im Trüben fischt.
Wir danken unserem Gast sehr herzlich für die interessanten Einblicke in die Welt der Spionage und wünschen viel Vergnügen!...
2023-10-081h 17
Im Gehörgang Ihrer Majestät | Der James Bond PodcastBond-News August 2023: 007-Ballett, ein verlorenes Moonraker-Drehbuch und Sebastian als Autor?Willkommen zu den Bond-Nachrichten! Heute mit folgenden Themen:
Harald Lesch über die Physik von James Bond
Ein Drehbuch von Ian Fleming zu Moonraker taucht auf
Die offizielle 007-Walking-Tour in London
Sky Dumont als James Bond?
007 als Ballett?
007's Road to a Million kommt im November
Sebastian als Autor?
und noch mehr!
---------
SPRECHT MIT UNS!
Twitter: @007PodcastDE
Facebook: @007PodcastDE
Instagram: instragram.com/007podcastde
Mail: podcast-007@outlook.de
Sprachnachrichten: https://w...
2023-08-2240 min
Die Skorpion und Batterie Show | Die On-Demand Late-Night-Show aus Berlin!Baywatch: Hochzeit auf Hawaii #DbPdWdraussenDas Podcast-Netzwerk "Die besten Podcasts der Welt" feiert den Themenmonat "Draussen". Die teilnehmenden Shows beschäftigen sich darin mit Themen, die auf die eine oder andere Art und Weise mit der Natur und der frischen Luft zu tun haben. Doch Commodore Schmidlabb hat sich schon im Rahmen des letzten Themenmonats mit Baywatch beschäftigt. Das kann er also nicht noch einmal bringen, oder?
Und wie er das kann! Zusammen mit dem unehelichen Sohn von Mitch Buchannon, Hendrik von "Bei Gin und Kerzenschein", beschäftigt er sich mit einem vielfach angeteasertem Baywatch-Meisterwerk. Darin steht Mitch nicht nur von den...
2023-07-201h 24
Im Gehörgang Ihrer Majestät | Der James Bond Podcast25 Jahre Der Morgen stirbt nie (Teil 2)Im zweiten Teil unserer Besprechung von Pierce Brosnans zweitem Auftritt als 007 beschäftigen wir uns mit David Arnolds erstem Beitrag für die Soundwelt von James Bond.
Außerdem schildert euch Sebastian, was er bei dem Studium der Filme von Michelle Yeoh über das Hongkong-Actionkino gelernt hat und warum es keine andere Frau für die Rolle der Wai-Lin geben konnte.
Hören könnt ihr seinen Gastauftritt bei allen gängigen Podcast-Anbietern oder auch direkt auf der Seite der „Männer, die auf Videos starren“: https://www.mdavs.de/portfolio/folge-79-michelle-yeoh-teil-1/
Diese Folge kom...
2023-07-061h 35
Die Skorpion und Batterie Show | Die On-Demand Late-Night-Show aus Berlin!Schieß mir ins Gesicht, Barbie!Auf den ersten Blick haben Barbie und Commodore Schmidlabb nicht viel gemeinsam. Doch wenn man genau hinschaut, sieht man, dass beide mal Architekt, bzw. Architektin waren, dass beide Ballett getanzt haben und dass beide mal Hosts ihrer eigenen Shows waren, bzw. sind. Das reicht dem ollen Schmidlabb aus, sich in seiner Rubrik „Nutzloses Partywissen“ intensiv mit der deutschen Herkunft der Plastikpuppe auseinanderzusetzen.
Doch vorher bespricht er mit der Baronesse van Munchhausen, warum es sich selbst für Nicht-GamerInnen lohnen könnte, anderen Menschen beim Spielen zuzusehen. Außerdem geben sie zahlreiche Tipps, mit welchen Let’s Plays interessie...
2023-06-111h 31
Im Gehörgang Ihrer Majestät | Der James Bond PodcastBond-News Mai 2023: 007's Road to a Million, Ken-Adam-Archive und der neue James-Bond-RomanWillkommen zu den Bond-Nachrichten! Heute mit folgenden Themen:
Erste Informationen zur Reality-TV-Show von Amazon Prime Video
Bond-Reisen von Black Tomato
Wir berichten von der Vorstellung von "The Ken Adam Archive"
Charlie Higson schreibt einen 007-Roman zur Krönung von King Charles III.
Das Besetzungskarussell dreht sich munter weiter
---------
Infos zu "The Ken Adam Archive"
TASCHEN
The Ken Adam Archive
Christopher Frayling
In Zusammenarbeit mit der Deutschen Kinemathek
Hardcover, in changierenden Bicolor-Stoff gebunden, mit 4-Phasen-Hologramm, 36 x 36 cm, 3,88 k...
2023-05-0234 min
Im Gehörgang Ihrer Majestät | Der James Bond Podcast25 Jahre Der Morgen stirbt nie (Teil 1)Wir feiern das 25-jährige Jubiläum von „Der Morgen stirbt nie“. Im ersten Teil der Retrospektive von Pierce Brosnans zweitem Auftritt als 007 blicken wir auf die turbulente Entstehungsgeschichte des Films.
Denn nicht nur der ewige Widersacher der Broccolis, Kevin McClory, machte wieder Ärger. Auch der Verkauf von MGM erhöhte den Druck auf die Filmcrew. Zudem beschäftigen wir uns mit der Frage, ob Paris Carver ein unterschätzter Charakter ist und welchen Einfluss das Phänomen „Girl Power“ auf den Film hatte.
Zuletzt beleuchten unsere Kolleginnen und Kollegen vom Klatsch- und Tratsch-Podcast „Hot Pink“ den damalige...
2023-04-262h 30
Die Skorpion und Batterie Show | Die On-Demand Late-Night-Show aus Berlin!Der tanzende Redakteur (feiert Geburtstag)Nicht jeder Geburtstag wird mit rauschenden Festen und Champagner-Exzessen gefeiert. Manchmal muss es auch das in der Einkaufstasche leicht angequetschte Yes-Törtchen sein, das an einer windigen Bushaltestelle schnell in den Schlund gedrückt wird. Doch auch ein leicht zerdrücktes Törtchen kann schmecken.
Die erste Schicht der Geburtstagstorte bietet euch exklusive Einblicke in den Arbeitsalltag eines Radio-Redakteurs. Dieser Tätigkeit geht Commodore Schmidlabb nämlich seit ein paar Monaten nach. Und als alte Klatschbase kann er natürlich nicht widerstehen, euch lang und breit zu erzählen, wie es beim Radio so abgeht.
In der z...
2023-03-291h 45
Im Gehörgang Ihrer Majestät | Der James Bond PodcastBond-News März 2023: Topol, Roman-Neuauflagen und Project 007Willkommen zu den Bond-Nachrichten! Heute mit folgenden Themen:
Goldeneye erscheint für Nintendo Switch Online und Xbox
Die Arbeiten an Bond 26 haben noch nicht begonnen
Michelle Yeoh gewinnt den Oscar als beste Hauptdarstellerin
Chaim Topol ist tot
Flemings Romane erscheinen mit neuen Covern und angepasst an moderne Zeiten
History's Greatest Heists mit Pierce Brosnan
Project 007 wird eine Ursprungsgeschichte zu James Bond
Bond-Konzert in Chemnitz
Ein neues Ken-Adam-Buch für Besserverdiener erscheint
---------
SPRECHT MIT UNS!
Tw...
2023-03-1936 min
Im Gehörgang Ihrer Majestät | Der James Bond PodcastDas James Bond Geburtstagsquiz 2023Zu unserem dritten Geburtstag haben wir wieder die Köpfe zusammengesteckt und für euch ein neues James-Bond-Quiz erstellt.
In der Sendung stellen sich diesmal Marcus, Lars (vom deutschsprachigen Bond-Lexikon) und Chris (vom Podcast Nerdizismus) den Fragen. Wer am Ende die Schlaumeier-Kappe tragen wird und welche Bond-ähnlichen Dinge wir tatsächlich schon mal getan haben, erfahrt ihr in dieser prall gefüllten Wundertüte!
Natürlich dürft ihr gerne auch an den Empfangsgeräten mitmachen. Lasst uns wissen, wie ihr abgeschnitten habt und solltet ihr Lust haben, euch im nächsten Jahr auch dem Wettbe...
2023-02-162h 18
Im Gehörgang Ihrer Majestät | Der James Bond PodcastSondersendung: Aaron Taylor-Johnson und die ganz große KunstIn dieser Sonderausgabe unseres Podcasts sprechen wir über das Gerücht, dass Aaron Taylor-Johnson die besten Karten im Pokerspiel um die größte Hauptrolle der Welt haben könnte. Doch auch ein anderer Name wird jetzt mit 007 in Verbindung gebracht.
Außerdem berichten wir von einer Ausstellung mit zahlreichen James-Bond-Autos in der Schweiz und geben euch einen Vorausblick auf den neuen 007-Fotoband "The Blofeld Files".
Unseren Reisebericht krönen wir mit einem besonderen Rundgang durch ein Museum, das gar keins ist.
Mail: podcast-007@outlook.de
Twitter: @007PodcastDE
Facebook: @007PodcastDE
Ins...
2023-01-201h 09
Die Skorpion und Batterie Show | Die On-Demand Late-Night-Show aus Berlin!Hurra, wir f**ken noch!Der olle Schmidlabb beweist wieder mal, dass er für Geld alles tun würde. Ein Hörer hat ihm nämlich Geld dafür geboten, dass er die Mamma-Mia-Filme guckt – etwas, was er freiwillig niemals getan hätte. Doch wird es das erwartete Waterloo für den Commodore oder wird er gar zur Dancing Queen der Herzen?
Außerdem geht es um das Brettspiel Scottland Yard als Umsetzung im echten Leben und eine fromme Freakzeitschrift.
Wir wünschen viel Vergnügen!
Alle Videos zur Show findet ihr hier:
https://www.mdavs.de/hurra-wir...
2023-01-181h 50
Im Gehörgang Ihrer Majestät | Der James Bond PodcastDer James-Bond-Kurzgeschichten-Wettbewerb 2022Die Zeit bis zum nächsten Bond-Abenteuer erscheint euch endlos? Da können wir helfen.
In unserem ersten Kurzgeschichten-Wettbewerb präsentieren wir euch fünf neue Geschichten mit dem bekanntesten Geheimagenten der Welt. Aufgabe des Wettstreits war es, ein Kapitel über ein Briefing mit Bond und M zu schreiben, in dem unser James den Auftrag erhält, den Mörder (oder die Mörderin) von 008 zu eliminieren. Wie, wo, wann und mit welchen weiteren Charakteren die Geschichte sich abspielt, war den Autorinnen und Autoren überlassen.
Damit ihr die Geschichten auch bestmöglich genießen könnt, haben w...
2022-12-143h 17
Im Gehörgang Ihrer Majestät | Der James Bond PodcastSondersendung: Das große James-Bond-Ranking (und "The Sound of 007")Heute wird es kontrovers! Ja, kontroverser als Éric Serras Soundtrack zu Goldeneye und sogar kontroverser als das Ende von "Keine Zeit zu sterben". Warum? Weil wir heute die Hosen runterlassen und unsere persönlichen Hitlisten der James-Bond-Filme veröffentlichen. Nach fast drei Jahren verraten wir euch endlich, welche 007-Filme bei uns ganz hoch in der Gunst stehen und welche weniger.
Außerdem gibt es unsere Eindrücke zum Bond-Konzert in der Royal Albert Hall und zur Dokumentation "The Sound of 007".
Falls ihr uns eure Hitliste wissen lassen wollt, findet ihr hier einige Kontaktmöglichkeiten und eine Ein...
2022-11-061h 47
Die Skorpion und Batterie Show | Die On-Demand Late-Night-Show aus Berlin!Baywatch Nilreb 1992 (feat. Akte X-Cast) | #DbPdW92Unser Podcast-Netzwerk feiert in seinem ersten Themenmonat das Jahr 1992. Doch womit könnte sich die Skorpion und Batterie Show im Rahmen des Themenmonats beschäftigen? Lange haben wir die Köpfe zusammengesteckt und dann nach harten aber ergebnislosen Brainstorming-Sessions gesagt "Warum machen wir nicht einfach wieder was mit Baywatch? Das kommt doch eigentlich immer ganz gut an."
Zum Glück hat Hendrik vom Akte X-Cast immer Lust über Hasselhoffs Rettungsschwimmer-Serie zu sprechen und so stürzen wir uns wie die Geier auf eine besonders seltsame Folge aus der zweiten Staffel aus dem Jahr 1992. In diesem seltsamen Crossover strand...
2022-10-271h 35
Im Gehörgang Ihrer Majestät | Der James Bond PodcastDeath is Forever von John Gardner | DbPdW92Unser Podcast-Netzwerk feiert den Themenmonat 1992 und alle teilnehmenden Shows beschäftigen sich mit Stoffen aus eben diesem Jahr. Für einen James-Bond-Podcast ist das gar keine so einfach Aufgabe. Schließlich fällt 1992 genau in das lange dunkle Tal zwischen "Lizenz zum Töten" und "Goldeneye". Doch immerhin ein Lebenszeichen des bekanntesten Geheimagenten der Welt aus dem Jahr 92 gibt es: John Gardners Roman "Death is Forever".
Gardners Werke genießen unter den Fans der Bücher aber einen zweifelhaften Ruf. Unsere Besprechung gewinnt zusätzliche Brisanz durch die Tatsache, dass dieser Gardner-Roman in Deutschland bislang noch nicht veröffen...
2022-10-201h 19
Im Gehörgang Ihrer Majestät | Der James Bond PodcastSondersendung: Dietmar Wunder, die deutsche Stimme von Daniel Craig im InterviewZur Feier des sechzigjährigen Leinwand-Jubiläums des berühmtesten Geheimagenten der Welt kredenzen wir euch eine kleine Reihe von Sonderfolgen unseres Podcasts.
Nachdem wir euch in der letzten Bonus-Episode einen Überblick über die Feierlichkeiten zum Global-James-Bond-Day gegeben haben, dürfen wir jetzt eine echte Größe der deutschsprachigen Bond-Fangemeinde begrüßen.
Deutschsprachig ist hier der entscheidende Hinweise, denn in dieser brandheißen Sonderausgabe von „Im Gehörgang Ihrer Majestät“ heißen wir Dietmar Wunder, die deutsche Feststimme von Daniel Craig, willkommen.
Dietmar Wunder hat James Bond aber nicht nur in Craigs fünf Kinoabenteuer...
2022-10-1628 min
Im Gehörgang Ihrer Majestät | Der James Bond PodcastSondersendung: Die 007-News zum Global James Bond DayDer Global James Bond Day steht vor der Tür! Es ist also an der Zeit, dass wir euch mit einem kleinen Rundumschlag auf alle bevorstehenden Aktivitäten zur Feier hinweisen. Außerdem lassen wir euch unsere Gedanken zur Christe's Auktion und der neuen Platte des Royal Symphonic Orchestra wissen. Als Olive in eurem Martini gibt's ein kleines Update zu unserem Kurzgeschichten-Wettbewerb.
Wir wünschen euch einen schönen Global James Bond Day!
Mail: podcast-007@outlook.de
Twitter: @007PodcastDE
Facebook: @007PodcastDE
Instagram: instagram.com/007podcastde/
Website: mdavs.de
...
2022-10-0354 min
Im Gehörgang Ihrer Majestät | Der James Bond PodcastWith a Mind to Kill von Anthony Horowitz – spoilerfreie ReviewDiesmal melden wir uns mit einer Breitseite bondigen Entertainments zurück. So besprechen wir mit unserem Gast Tim nicht nur die James-Bond-News, wir beantworten darüberhinaus eure Fragen zur Zukunft des Franchises. Als Kirsche auf der Bomb Surprise könnt ihr in unserer spoilerfreien Review erfahren, ob sich der neue 007-Roman von Anthony Horowitz mit den Werken von Ian Fleming messen kann.
Twitter: @007PodcastDE
Facebook: @007PodcastDE
Instagram: instragram.com/007podcastde
Website: https://www.mdavs.de/im-gehoergang-ihrer-majestaet-james-bond-podcast/
Einladung-Link zu Discord (5x und eine Woche lang gültig)
https://discord.gg/Y...
2022-09-062h 17
Die Skorpion und Batterie Show | Die On-Demand Late-Night-Show aus Berlin!Die toten Augen von Bibi und TinaDas lange Warten hat endlich (?) ein Ende. Nachdem er lange um das beliebte Pferde-Franchise herumgetanzt ist, widmet sich Commodore Schmidlabb nun tatsächlich Bibi und Tina. So nimmt er in einer ausführlichen Review das Spiel zum ersten Kino-Abenteuer auseinander und erlebt darin unerwartet gruselige Momente und apokalyptische Einsamkeit.
Davor wirft er in seiner Rubrik "Nutzloses Partywissen" einen genauen Blick auf die Geschichte einer vergangenen Trinkkultur und wird dafür selbst zum Cocktailmixer. Die zur Rubrik gewordenen Youtube-Empfehlungen dürfen natürlich auch nicht fehlen. So stellt euch der Commodore einen Youtube-Kanal für Fans von lauten Knack-G...
2022-08-2954 min
Im Gehörgang Ihrer Majestät | Der James Bond PodcastPassport to Oblivion mit George Lazenby (Hörspiel)In unserer neuen Folge darf George Lazenby endlich die Rolle spielen, für die er geboren wurde – nein, nicht James Bond. Wir meinen den alternden australischen Ladies' Man Dr. Jason Love! Der vom britischen Autor James Leasor erfundene "Agent wider Willen" erlebte seit den 60er Jahren des letzten Jahrhunderts eine ganze Reihe von Abenteuern.
Doch erst jetzt gibt es eine adäquate Audio-Umsetzung seiner ersten Mission "Passport to Oblivion" mit Lazenby in der Hauptrolle. Begleitet wird unsere Besprechung des Hörbuchs von einem kurzen Ausflug in die Welt der Überläufer, dem Lebenslauf von James Leasor und natürli...
2022-07-181h 22
Die Skorpion und Batterie Show | Die On-Demand Late-Night-Show aus Berlin!Elfenohren statt Heroin (feat. Das E&U-Gespräch)Die Welt kann so schön sein. Sie kann aber auch ein sehr unfreundlicher Ort sein. Doch wie kann man der buchstäblich allgegenwärtigen Welt entfliehen, wenn das Fass mal wirklich überzulaufen droht? Über Möglichkeiten zur Weltflucht berät sich Commodore Schmidlabb mit seinem Sidekick, Stammgast Christian und Podcast-Kollege Markus (von Das E&U-Gespräch).
Diskutiert wird zum Beispiel darüber, mit welcher Philosophie wir auf das Leben sehen, wie wir mit Stress umgehen und welches Problem der Commodore mit Elfenohren hat. Außerdem verraten wir euch, welche Medien uns beim Eskapismus behilflich sind. Mit dabei: spr...
2022-06-082h 26
Im Gehörgang Ihrer Majestät | Der James Bond PodcastDer Mann mit dem goldenen Colt (Roman)Wir eröffnen das große 007-Literaturjahr für alle James-Bond-Fans mit unserer Besprechung des Buchs "Der Mann mit dem goldenen Colt". So könnt ihr euch auf den nötigen Wissensstand bringen, bevor Anthony Horowitz mit "A Mind to Kill" an den letzten Roman von Ian Fleming anknüpft. Außerdem verraten wir euch, welche Aspekte der Geschichte wir uns für eine direkte Verfilmung vorstellen können.
Zuletzt gibt es noch alle Informationen zur Teilnahme an unserem James-Bond-Kurzgeschichten-Wettbewerb. Ihr könnt alle Infos auch hier runterladen: https://bit.ly/3yNCBtD
***
Mail: podcast-00...
2022-05-192h 19
Im Gehörgang Ihrer Majestät | Der James Bond PodcastJames Bond Junior – Folge 01: Der erste SchultagErinnert ihr euch an James Bond Junior? Nein? Damit seid ihr nicht alleine, denn die Zeichentrickserie aus den 90ern ist das rothaarige Stiefkind des 007-Franchise – oder besser gesagt, der braunhaarige Neffe. Wie der Name schon andeutet, richtete sich die Show die Abenteuer an Kinder und sollte aus ihnen glühende Bond-Fans machen.
Warum dieser Versuch krachend gescheitert ist, besprechen wir in unserer Review der ersten Folge "Der erste Schultag". Doch wir finden auch Sachen, die uns zum Schmunzeln bringen und sogar einige Dinge, die Potential hätten, bei James Senior zum Einsatz zu kommen. Außerdem beleuchten wir d...
2022-04-131h 17
Die Skorpion und Batterie Show | Die On-Demand Late-Night-Show aus Berlin!Kinder-Detektiv Amal ermittelt!Obwohl sie stramm auf die 100 Jahre zugeht und in weiten Teilen der Welt auf eine treue Fangemeinde zählen kann, kennt hierzulande so gut wie niemand Nancy Drew. Das wird sich jetzt ändern, denn Commodore Schmidlabb wird euch die jugendliche Detektivin vorstellen.
Zusammen mit seinem zweiten Detektiv, Amal vom Musikpodcast Zimmerlautstärke, hat er nämlich das vielleicht erste deutschsprachige Nancy-Drew-Hörbuch aufgenommen.
Richtig gelesen! Die beiden lesen nach einer Einführung zum Franchise den kompletten Roman "Der Mann in Schwarz" vor. Das Beste daran? Ihr könnt zusammen mit Amal versuchen, den Diamantenraub auf der Ballett...
2022-04-063h 31
Im Gehörgang Ihrer Majestät | Der James Bond PodcastDas James Bond Geburtstagsquiz 2022Doppelt oder Nichts! Wir feiern unsern zweiten Geburtstag und bitten unsere drei Gäste an den Spieltisch. In diesem Jahr messen sich Cornelius von "Das Daumenkino", Moritz vom Rollenspiel-Podcast "Gruftschrecken" und Benjamin von "The Bond Experience" in unserem James-Bond-Quiz. Zwischen den Runden stellen wir euch diese Prachtexemplare der 007-Fancommunity genauer vor. Außerdem diskutieren wir gemeinsam, ob "Keine Zeit zu sterben" nun ein Schuss in den Ofen war oder nicht und wie die Zukunft von James Bond aussehen könnte.
Wir bedanken uns beim Schilthorn Piz Gloria (https://schilthorn.ch) für die Bereitstellung des wunderbaren Preises und...
2022-02-162h 36
Im Gehörgang Ihrer Majestät | Der James Bond Podcast50 Jahre Diamantenfieber – Teil 2: Ein Film wie ein Traum?Auch im zweiten und letzten Teil unserer Rückschau auf "Diamantentfieber" bemühen wir uns, euch neue Sichtweisen auf das kontroverse 007-Abenteuer zu eröffnen. So diskutieren wir die These eines spannenden Artikels, der behauptet, dass der Film ein Werk des Surrealismus sei. Außerdem machen wir Ausflüge in die Architektur des Films und erklären euch, warum das Sounddesign des Films ein extra Lob verdient.
Mail: podcast-007@outlook.de
Twitter: @007PodcastDE
Facebook: @007PodcastDE
Instagram: instragram.com/007podcastde
Website: mdavs.de
Einladung-Link zu Discord (5x und eine Woc...
2022-02-022h 04
Im Gehörgang Ihrer Majestät | Der James Bond Podcast50 Jahre Diamantenfieber – Teil 1: Ein Film wie ein voller Aschenbecher?Im ersten Teil der Fünfzigjahrfeier zu Connerys (vorerst) letztem Auftritt als 007 diskutieren Kai und Sebastian, warum Diamantenfieber wie ein voller Aschenbecher nach einer Partynacht wirkt – und warum das nicht unbedingt schlecht sein muss.
Außerdem klären sie auf, warum der Soundtrack ein echtes Highlight ist und was den Film mit der Frauenzeitschrift Brigitte verbindet. Obendrauf noch ein bisschen Bond-News und fertig ist die Bombe Surprise!
Mail: podcast-007@outlook.de
Twitter: @007PodcastDE
Facebook: @007PodcastDE
Instagram: instragram.com/007podcastde
Website: mdavs.de
Learn more ab...
2021-12-251h 42
Im Gehörgang Ihrer Majestät | Der James Bond PodcastSondersendung: Brigitte Millar aus "Spectre" und "Keine Zeit zu sterben" im InterviewStar Power bei „Im Gehörgang Ihrer Majestät“! Wir haben die Ehre und das Vergnügen, Brigitte Millar bei uns begrüßen zu dürfen. Frau Millar durfte 007 in der Rolle von Dr. Vogel in „Spectre“ und „Keine Zeit zu sterben“ das Leben schwer machen. Von ihr erfahren wir neben interessanten Geschichten von den Sets, wie sich die Arbeitsweisen von Sam Mendes und Cary Joji Fukunaga unterscheiden und was für ein Mensch Dr. Vogel war. Zum Schluss rätseln wir gemeinsam über die Zukunft des Franchises. Wir wünschen viel Spaß und ein frohes Fest!
Mail: podcas...
2021-12-2148 min
Die Skorpion und Batterie Show | Die On-Demand Late-Night-Show aus Berlin!Nutten-Airhockey mit Bill ClintonIn der letzten Folge des Jahres präsentiert euch Commodore Schmidlabb eine Reihe von Freizeit-Tipps, um die Tristesse der Feiertage zwischen den Jahren zu vertreiben. Es geht los mit einem Einblick in die Welt des Freaksports. Dort kann man seine Zeit auf dem Sofa nicht nur mit professionellem Schafehüten verbringen, sondern auch mit der Meisterschaft der Elektriker und ähnlich absurden Sportarten.
Weiter geht es mit Buchtipps. Mit dabei: ein Agententhriller von Bill Clinton und ein Lexikon der ausgestorbenen Nationen.
Die Folge schließt mit einer Besprechung des diesjährigen Prix de Lausanne. Die "Olympiade des Bal...
2021-12-191h 29
Im Gehörgang Ihrer Majestät | Der James Bond PodcastCamp is Forever or: How I learned to stop worrying and love Diamonds are Forever (With Licence to Queer)English Interview starts at 02:13 Minutes
GERMAN DESCRIPTION:
Bevor wir uns zum 50-jährigen Jubiläum von „Diamantenfieber“ der Geschichte des Films widmen können, müssen wir zuerst ein bisschen die Schulbank drücken. Unser Lehrer David von „Licence to Queer“ wird uns die Grundlagen beibringen, die man benötigt, um das kontroverse Abenteuer von 007 besser verstehen zu können. David wird uns erklären, was Camp ist und warum der Film ein Camp-Meisterwerk ist. Außerdem beantworten wir die Frage, warum der Humor des Films so speziell ist und warum Charles Grays Darstellung von Blofeld doch liebenswert is...
2021-12-061h 46
Die Skorpion und Batterie Show | Die On-Demand Late-Night-Show aus Berlin!Besoffen und wütend im ZeitungskioskDie Corona-Epidemie hält euch mit dem Arsch auf dem Sofa fest, obwohl ihr gerne Party machen würdet? Kein Problem. Die Skorpion und Alkohol Show bringt euch die besoffenen Gäste nach Hause!
Im stark angeheiterten Zustand bespricht Commodore Schmidlabb mit seinen Gästen Tobias und Dominik die Top 5 der Kleinigkeiten, die sie zur Weißglut bringen. Außerdem stellen sie eine neue Auswahl seltsamer Magazine vor – von einer emotionsgeladenen Frauenzeitschrift, über ein bewusst hässliches Modemagazin und einem Heft nur für Raucher bis zum einzigen Fan-Magazin, was die Welt wirklich braucht. Plötzlich vermisst man...
2021-11-243h 31
Im Gehörgang Ihrer Majestät | Der James Bond PodcastKeine Zeit zu sterben Review (spoilerfrei) mit Danny MorgensternNach langen Monaten des Wartens läuft „Keine Zeit zu sterben“ nun endlich in den Kinos. Mit unserem Stargast, dem 007-Experten Danny Morgenstern, besprechen wir, ob diese Geduld belohnt wird. Allen, die den Film noch nicht gesehen haben, können wir Entwarnung geben. Unsere Review verrät euch keine Details der Geschichte des neuen Abenteuers von James Bond. Außerdem geben euch unser Hörer Lars und Mr. Morgenstern himself ihre Eindrücke von beiden Seiten des roten Teppichs wieder.
Mail: podcast-007@outlook.deTwitter: @007_Podcast_DE
Facebook: @007PodcastDE
Instagram: instragram.com/007_podcast_de
Website: mdavs.de
Learn more a...
2021-10-071h 32
Im Gehörgang Ihrer Majestät | Der James Bond PodcastSondersendung: No Time to Die Preview inkl. Being James BondEs dauert nicht mehr lange, dann können wir tatsächlich das neue 007-Abenteuer Keine Zeit zu sterben im Kino bewundern. Um die Stimmung weiter anzufeuern, haben Kai und Sebastian daher eine kleine Sondersendung aufgenommen. Darin sprechen Sie über die Neuigkeiten zum Film, wo und wie sie den Film schauen werden und die Daniel-Craig-Doku Being James Bond. Außerdem verraten sie euch, auf welche Elemente von Keine Zeit zu sterben sie sich besonders freuen und welche ihnen etwas Sorge bereiten.
Mail: podcast-007@outlook.de
Twitter: @007PodcastDE
Facebook: @007PodcastDE
Instagr...
2021-09-2347 min
Die Skorpion und Batterie Show | Die On-Demand Late-Night-Show aus Berlin!Kleinparteien zum BundeswahlkrampfEuch überzeugen die die großen Parteien im Wahlkampf zur Bundestagswahl 2021 nicht? Ihr liebäugelt damit, eine Kleinpartei zu wählen? Dann können wir euch helfen, etwas Licht in den Dschungel der immer unübersichtlicheren Parteienlandschaft zu bringen.
Wir stellen euch gleich vier Parteien vor, die ihr vielleicht noch nicht auf dem Schirm habt: die Thüringer Heimatpartei, die menschliche Welt, die Gartenpartei und die Bergpartei. Außerdem erklären wir euch, warum es durchaus Sinn machen kann, eine kleine Partei zu wählen und welche Gruppierungen uns der Wahl-O-Mat empfiehlt.
Feedback an:
Mail: subs-podcast@hotmail.com
Twitter: @P...
2021-09-122h 03
Die Skorpion und Batterie Show | Die On-Demand Late-Night-Show aus Berlin!Travelling without moving: Die ReiseshowIn der aktuellen Folge der Skorpion und Batterie Show nimmt euch Commodore Schmidlabb mit auf eine Reise quer durch die ganze Welt – und das, ohne auch nur einen Schritt tätigen zu müssen! In seiner Episode zum Thema Zimmerreisen, geht es von der hässlichsten Stadt NRWs über eine Rikscha-Fahrt durch Kyoto bis zu den grünen Hügeln von Wales. Außerdem gibt es noch ein kleines Spiel zum Mitmachen. Also schnell die Wanderschuhe wieder ausziehen und auf die Couch setzten!
Alle Bilder und Videos zur Sendung (Auch die Bilder für das Mitmach-Spiel) gibt es auf unserem Bl...
2021-09-1042 min
Im Gehörgang Ihrer Majestät | Der James Bond PodcastLeben und sterben lassen (Teil 3) – Auf dem Highway ist der Pepper los!Im dritten und letzten Teil unserer Retrospektive zu Roger Moores Debüt gehen wir über Tische und Bänke... und Krokodile. In einem kleinen Exkurs erfahrt ihr außerdem, was der sogenannte Peacock-Chair mit dem Film zu tun hat und wer eigentlich Big Heinz ist. Zuletzt diskutieren wir, ob der Film das Highway-Chaoten-Genre der 70er und 80er vorweg genommen hat. Natürlich gibt es auch wieder reichlich Bond-News. Wir wünschen viel Vergnügen.
Mail: podcast-007@outlook.de
Twitter: @007_Podcast_DE
Facebook: @007PodcastDE
Instagram: instragram.com/007_podcast_de
Website: mdavs.de
Learn more about your ad choice...
2021-09-031h 56
Im Gehörgang Ihrer Majestät | Der James Bond PodcastLeben und sterben lassen (Teil 2) – New Orleans sehen und sterbenIm zweiten Teil der Besprechung zu Roger Moores erstem Auftritt als 007 geht es endlich los mit der Besprechung des Films. Doch natürlich tauchen Kai und Sebastian auch wieder in die Tiefe ab, diesmal zum Thema Musik. Während Sebastian eine ausführliche Analyse des Titelsongs von Paul McCartney vorträgt, überrascht Kai mit einer kontroversen Meinung zum Ex-Beatle.
Außerdem besprechen die beiden die wichtigste Bond-News der letzten Monate: die Übernahme von MGM durch das Evil Empire Amazon. Die wichtigste Nachricht ist für Kai allerdings die Ankündigung, dass Anthony Horowitz einen dritten James-Bond-Roman verfassen wird.
All das un...
2021-07-202h 00
Die Skorpion und Batterie Show | Die On-Demand Late-Night-Show aus Berlin!Baywatch Nilreb Nights – S02 E02 "Die Kreatur" (feat. Akte X-Cast)Wie jeder weiß, ist David Hasselhoff ein Renaissance-Man, der wirklich alles kann. Zumindest glaubt er das und so ließe sich auch das Debakel um Baywatch Nights erklären.
Der Mystery-Ableger der Rettungsschwimmer von Malibu genießt unter Trash-Fans einen legendären Ruf. Kein Wunder, dass Commodore Schmidlabb und sein Kollege Hendrik da nicht widerstehen können und erneut zu den Mikrofonen greifen.
Besprochen wird die zweite Folge der zweiten Staffel, in der eine Katzen- oder Reptilien- oder Fisch-Frau (Man weiß es nicht genau) aus einem Labor ausbricht und auf Männerjagd geht.
Hört sich doof an? Ist es...
2021-07-061h 12
Im Gehörgang Ihrer Majestät | Der James Bond PodcastLeben und sterben lassen (Teil 1) – Gestatten Moore, Roger MooreDiesen Monat starten Kai und Sebastian ihre mehrteilige Reihe über Roger Moores Debüt „Leben und sterben lassen“. Im ersten Teil erläutern die beiden, wie der Londoner Polizistensohn zu James Bond wurde. Natürlich stellen sie auch Cast und Crew vor und blicken zurück auf das Leben von Yaphet Kotto. Außerdem erklärt Kai, was das Genre Blaxploitation ausmacht und ob sich der Film ihm zurechnen lässt. Oben drauf gibt es die Bond-News und eine Menge Hausaufgaben für Sebastian.
Unser merchandise findet ihr hier:
https://www.mdavs.de/podcast-merchandise-2/
Mail: podcast-007@outlook.de
Tw...
2021-05-191h 35
Die Skorpion und Batterie Show | Die On-Demand Late-Night-Show aus Berlin!Die Charts ferner Länder (feat. Zimmerlautstärke)In der neuen Folge der Skorpion und Batterie Show hat Commodore Schmidlabb gleich zwei Gäste im Studio. Mit den Kollegen Martin und Amal vom Musikpodcast Zimmerlautstärke guckt, bzw. hört er sich die Top 10 der Musikcharts ferner Länder an. Genauer gesagt geht es um die größten Hits in Ghana, Burkina Faso und Thailand. Außerdem gibt's mit Videos über transparentes Holz (!) und die HD-VHS noch ein bisschen Youtube-Munition gegen die Langeweile.
Alle Links zur Show findet ihr unter:
https://www.mdavs.de/die-skorpion-und-batterie-show-erklaert-euch-die-charts-ferner-laender/
Feedback an:
Mail: subs-podcast@hotmail.com
Twitter: @PodcastSubs
Website: www.mdav...
2021-05-142h 00
Im Gehörgang Ihrer Majestät | Der James Bond PodcastGoldeneye für das N64Diesen Monat blickt Kai auf den Videospiel-Klassiker Goldeneye für das Nintendo 64. Dazu hat er sich mit Eric, Hakan und Cornelius gleich drei Mitspieler eingeladen. Mit ihnen spricht er über die Frage, was genau Goldeneye eigentlich so großartig macht.
Ergänzt werden sie dabei durch einen Gastbeitrag von Hardy Heßdörfer (Nerdwelten Podcast), der die Geschichte des Spiels zusammenfasst.
Zum Schluss spricht das Quartett über den legendären Multiplayer-Modus und gibt ein erstes Urteil zum Leak der Xbox 360-Version des Spiels ab. Also schnell die PP7 wegstecken und reinhören!
Mail: podcast-007@outlook.de
Twitter: @007_Podcast_DE
Faceboo...
2021-04-072h 17
Die Skorpion und Batterie Show | Die On-Demand Late-Night-Show aus Berlin!Mittelmäßigkeit is back, Baby!Bringt die Videokassetten mit alten Aufnahmen der Harald-Schmidt-Show wieder in den Keller – Die Skorpion und Batterie Show ist zurück!
In eurem Late-Night-Podcast für die geistige Elite Deutschlands holt Commodore Schmidlabb in der ersten regulären Folge zum Rundumschlag aus. So präsentiert er euch nicht nur die beste Spam-Mail aller Zeiten, sondern auch noch eine für Kinderohren komplett ungeeignete Komposition.
Außerdem in der Show: Schmidlabbs neuer Fernseher, Konzerte fürs Wohnzimmer und die Rückkehr der Freakzeitschriften!
Feedback an:
Mail: subs-podcast@hotmail.com
Twitter: @PodcastSubs
Website: www.mdavs.de
Die Skorpion und Batterie Sho...
2021-04-0451 min
Die Skorpion und Batterie Show | Die On-Demand Late-Night-Show aus Berlin!Die Skorbut und Diphtherie Show – Folge 14: Erreiche jetzt dein Traumgewicht und verdiene 6.000 Euro am Tag und habe unendlich viel Sex mit diesem einfachen Trick!Bevor die reguläre Skorpion & Batterie Show zurückkehren kann, muss der Lockdown-Podcast sterben. Zeit also, der Skorbut & Diphtherie Show Lebewohl zu sagen. Doch bevor wir uns verabschieden gibt es noch eine dicke Ladung Doku-, Gameshow- und Musiktipps. Außerdem: Die nackte Kanone 5 und Rap von Nichtsblickern.
Alle Links zur Folge:
https://www.mdavs.de/suds-sagt-goodbye/
Mails an: subs-podcast@hotmail.com
Twitter: @PodcastSubs
Website: mdavs.de
Podcast unterstützen: https://www.mdavs.de/unterstuetzen/
2021-02-281h 19
Die Skorpion und Batterie Show | Die On-Demand Late-Night-Show aus Berlin!Die Skorbut und Diphtherie Show – Folge 13: Flüssiger Hummer zum Geburtstag!Die Skorpion und Batterie Show wird zwei Jahre alt! Gefeiert wurde das mit der bislang längsten Folge in der Geschichte der Sendung. Damit wir die Sendezeit nicht allein füllen müssen, haben wir einen Gast eingeladen und ein paar Hörerfragen beantwortet. Außerdem geht es in dieser pickepackevollen Episode um Zitronensprudel, die Jagd nach Bigfoot und Deutschpunk. Zum Schluss bekommen wir von unseren Hörern zwei schreckliche Aufgaben gestellt… Na dann, Happy Birthday.
Alle Links zur Folge:
https://www.mdavs.de/fluessiger-hummer-zum-geburtstag-die-skorpion-batterie-show-wird-zwei-jahre-alt/
Mails an: subs-podcast@hotmail.com
Twitter: @PodcastSubs
Website: mdavs.de
Podcast u...
2021-02-221h 49
Im Gehörgang Ihrer Majestät | Der James Bond PodcastDas James Bond GeburtstagsquizUnser kleiner James-Bond-Podcast feiert Geburtstag! Daher haben wir uns gleich drei Gäste eingeladen und spielen mit Ihnen ein Quiz. Das Beste? Auch ihr könnt mitmachen! Einfach einen Stift in die Hand nehmen und die Fragen beantworten. Wir würden uns freuen, zu hören, wie ihr bei unserem 007-Ratespiel abgeschnitten habt. Also lasst es uns wissen. Die nötigen Kontaktdaten findet ihr in der Folgenbeschreibung.
Unser Merchandise:
https://www.mdavs.de/podcast-merchandise/
Mail: podcast-007@outlook.de
Twitter: @007_Podcast_DE
Facebook: @007PodcastDE
Instagram: instragram.com/007_podcast_de
Website: mdavs.de
Learn more about your ad choi...
2021-02-171h 51
Die Skorpion und Batterie Show | Die On-Demand Late-Night-Show aus Berlin!Die Skorbut und Diphtherie Show – Folge 12: Bigger than Jesus!Da wir uns diese Woche nicht beherrschen konnten, müsst ihr eine extralange Episode der Skorbut & Diphtherie Show ertragen. Grund dafür ist auch, dass der American Cyborg Terminator endlich mal ohne Zeitbeschränkung sein nutzloses Partywissen verbreiten durfte. Daher dürft ihr euch spannende Geschichten über Blasenfolie, atomare Unfälle und den deutschen Elon Musk freuen. Dazu gibt es Tipps für den inneren Frieden und den akustischen Genuss. Natürlich dürfen auch unsere Mitmach-Aufgaben nicht fehlen.
Alle Links zur Sendung: https://www.mdavs.de/die-skorbut-und-diphtherie-show-bigger-than-jesus/
Mails an: subs-podcast@hotmail.com
Twitter: @PodcastSubs
Website: mdavs.de
Podc...
2021-02-1550 min
Die Skorpion und Batterie Show | Die On-Demand Late-Night-Show aus Berlin!Die Skorbut und Diphtherie Show – Folge 11: Spielen wir im Alter immer noch Doom?In dieser Folge erklärt euch Commodore Schmidlabb, wie man am besten eine Katze verwirren kann. Sein Kollege stellt dafür seinen Fan-Song für die Iserlohn Roosters vor. Außerdem beschäftigen wir uns mit der Frage, ob wir im Alter noch Videospiele spielen werden, oder ob uns schon der Schaukelstuhl überfordern wird. Zum Schluss gibt es noch eine ganze LKW-Ladung Musiktipps und zwei neue Mitmach-Aufgaben zum Zeitvertreib.
Alle Links zur Sendung: https://www.mdavs.de/die-skorbut-und-diphtherie-show-fragt-spielen-wir-im-alter-immer-noch-doom/
Mails an: subs-podcast@hotmail.com
Twitter: @PodcastSubs
Website: mdavs.de
Podcast unterstützen: https://www.mdavs.de/unterstuetzen/
2021-02-0840 min
Die Skorpion und Batterie Show | Die On-Demand Late-Night-Show aus Berlin!Die Skorbut und Diphtherie Show – Folge 10: Die große Fuß-FolgeKann man absichtlich einen schlechten Podcast produzieren? JA! lautet unsere eindeutige Meinung. Zumindest, wenn man das "richtige“ Thema hat, sollten die Hörer:innen die Beine in die Hand nehmen. Und was sieht man, wenn man die Beine in die Hand nimmt? Richtig, die eigene Füße. Und um das Kellergeschoss des Körpers soll es auch in unserer neuen Folge gehen. Wir beschäftigen uns mit den Fuß-News, dem Fetischfotografen Elmer Batters, dem Verhältnis zu den eigenen Füßen und obendrein gibt’s sogar Musik für Mauken. Donnerwetter!
Wer eine der versprochenen Postkarten haben möchte, bitte...
2021-02-0142 min
Im Gehörgang Ihrer Majestät | Der James Bond PodcastVARGR – der Reboot der 007 Comics von Warren EllisDiesmal besprechen Kai und Sebastian den Reboot der 007-Comics vom Dynamite-Verlag. Dazu holen sie sich fachkundige Hilfe von Björn, mit dem sie bereits den Roman SOLO besprochen haben. Doch wird das Trio voll des Lobes für das Werk von Starautor Warren Ellis sein oder werden sie die Roger-Moore-Augenbraue heben? Obendrein gibt es noch die Nachrichten aus der Welt von 007 und etwas zu gewinnen.
Mail: podcast-007@outlook.de
Twitter: @007_Podcast_DE
Facebook: @007PodcastDE
Instagram: instragram.com/007_podcast_de
Website: mdavs.de
Learn more about your ad choices. Visit megaphone.fm/adchoices
2021-01-262h 18
Die Skorpion und Batterie Show | Die On-Demand Late-Night-Show aus Berlin!Die Skorbut und Diphtherie Show – Folge 09: Leben wir in einer Simulation und wie wütend ist Sie?Auch bei der Skorbut und Diphtherie Show ist nur der Wandel beständig. Daher quatschen wir diesmal nicht über das, was wir bei Youtube gesehen haben. Stattdessen diskutieren wir die uralte Frage, ob wir in einer Simulation leben.
Zumindest versuchen wir das. Denn einer der Teilnehmer an diesem Streitgespräch hat das mit dem Streit recht wörtlich genommen und explodiert wie eine Supernova. Ob wir uns dennoch wieder einkriegen und welche Podcasts man zum Thema hören sollte, erfahrt ihr hier!
Alle Links zur Folge findet ihr hier:
https://www.mdavs.de/die-skorbut-und-diphtherie-show-diskutiert-leben-wir-in-einer-simulation-und-wie-wuetend-ist-sie/
Feedback an:
M...
2021-01-2451 min
Die Skorpion und Batterie Show | Die On-Demand Late-Night-Show aus Berlin!Die Skorbut und Diphtherie Show – Folge 08: Saufen wie ein GenieDie Skorbut und Diphtherie Show ist zurück und bläst zum Großangriff auf eure Freizeit. Neben den üblichen Musiktipps gibt es diesmal auch einige Empfehlungen für die Leseratten unter euch. Außerdem pflegen wir unsere Liebe zu englischen Gameshows und präsentieren euch den BESTEN YOUTUBE-KANAL DES UNIVERSUMS!
Alle Links zur Folge findet ihr hier:
https://www.mdavs.de/die-skorbut-und-diphtherie-show-praesentiert-tipps-fuer-dumme-und-schlaue-menschen/
Feedback an:
Mail: subs-podcast@hotmail.com
Twitter: @PodcastSubs
Website: mdavs.de
Podcast unterstützen: https://www.mdavs.de/unterstuetzen/
2021-01-1845 min
Die Skorpion und Batterie Show | Die On-Demand Late-Night-Show aus Berlin!Die Skorbut und Diphtherie Show – Folge 07: Hilfe, meine Katze ist spielsüchtig!Herzlich willkommen zur großen Weihnachtsgala der Skorbut & Diphtherie Show! In dieser extralangen Ausgabe unseres Corona-Podcasts machen wir einen thematischen Rundumschlag – von spielsüchtigen Katzen, über Kaffee-Influencer bis zur Unfähigkeit, Hip-Hop zu verarbeiten. Zum Schluss beantworten wir auch noch ein paar persönliche Fragen über unsere Selbstwahrnehmung und die eigene Beerdigung (Ja, wir wissen… sehr weihnachtlich).
Alle Links zur Folge findet ihr hier:
https://www.mdavs.de/die-grosse-skorbut-diphtherie-show-weihnachtsgala/
Feedback an:
Mail: subs-podcast@hotmail.com
Twitter: @PodcastSubs
Website: mdavs.de
2020-12-181h 20
Die Skorpion und Batterie Show | Die On-Demand Late-Night-Show aus Berlin!Trailer – Skorpion und Batterie ShowDie Skorpion und Batterie Show – Der beste Podcast, den niemand hört!
Mehr Informationen und alle Folgen unter:
https://www.mdavs.de/die-skorpion-und-batterie-show/
2020-12-1801 min
Im Gehörgang Ihrer Majestät | Der James Bond PodcastQuo vadis 007? – die Zukunft des Bond-Franchises (Spoiler)MGM in finanziellen Schwierigkeiten, No Time to Die auf lange Zeit verschoben und Daniel Craig auf dem Absprung... Viele Fragezeichen schweben über der Zukunft von 007.
Im Gespräch mit Wolfgang Thürauf vom James Bond Club Deutschland diskutieren wir, wie es mit dem Bond-Franchise weitergehen könnte. Außerdem schildert unser Gast, was der James Bond Club Deutschland eigentlich so macht. Zum Schluss schauen wir in die Kristallkugel und geben unsere Prognosen zu No Time to Die ab.
SPOILERWARNUNG!
Mail: podcast-007@outlook.de
Twitter: @007_Podcast_DE
Facebook: @007PodcastDE
Instagram: instragram.com/007_podcast_de
Webs...
2020-12-131h 18
Die Skorpion und Batterie Show | Die On-Demand Late-Night-Show aus Berlin!Die Skorbut und Diphtherie Show – Folge 06: Spiel mir die Eier-Gitarre, Baby!Es wird musikalisch in der Skorbut & Diphtherie Show. Commodore Schmidlabb stellt seine Eier-Gitarre vor und sein Kollege präsentiert seinen gesungenen Podcast-Trailer. Außerdem diskutieren die beiden, welche deutschen Süßigkeiten in ein Care-Paket gehören. Natürlich gibt es auch neue Musik-Tipps und Aufgaben zum Mitmachen.
Alle Links zur Sendung gibt es auf unserem Blog!
https://www.mdavs.de/blog-trash-o-meter/
Feedback an:
Mail: subs-podcast@hotmail.com
Twitter: @PodcastSubs
Website: mdavs.de
Mailbox unter: 030 - 20 84 86 83
2020-12-1138 min
Die Skorpion und Batterie Show | Die On-Demand Late-Night-Show aus Berlin!Die Skorbut und Diphtherie Show – Folge 05: Welcome to the Land Down Under!Welcome to the Land Down Under! Die Skorbut und Diphtherie Show feiert die Deutsch-Australische-Freundschaft. Der American Cyborg Terminator 2K präsentiert diesmal gleich drei verschiedene Wege, wie Commodore Schmidlabb seiner australische Hörerschaft wieder zurückgewinnen kann. Außerdem gibt es Lo-Fi aus London, Thrash-Metal aus Schweden und Überlebenstipps für die Endzeit in Norwegen.
Alle Links zur Sendung gibt es auf unserem Blog!
https://www.mdavs.de/blog-trash-o-meter/
Feedback an:
Mail: subs-podcast@hotmail.com
Twitter: @PodcastSubs
Website: mdavs.de
Mailbox unter: 030 - 20 84 86 83
2020-12-0636 min
Die Skorpion und Batterie Show | Die On-Demand Late-Night-Show aus Berlin!Die Skorbut und Diphtherie Show – Folge 04: Das Festival der Genital-LiteraturWillkommen zum Festival der Genital-Literatur! Während Commodore Schmidlabb seine erotische Gute-Nacht-Geschichte über einen Prinzen mit einem krummen Penis vorliest, stellt sein Kollege das Prequel zum „Sackabreißer von Wattenscheid“ vor. Und es geht auch literarisch weiter – mit feministischen Spaziergängen und besoffenen Läufern. Natürlich gibt es auch wieder Musiktipps und neue Aufgaben zum Mitmachen.
Alle Links zur Sendung gibt es auf unserem Blog!
https://www.mdavs.de/blog-trash-o-meter/
Feedback an:
Mail: subs-podcast@hotmail.com
Twitter: @PodcastSubs
Website: mdavs.de
Mailbox unter: 030 - 20 84 86 83
2020-11-2634 min
Im Gehörgang Ihrer Majestät | Der James Bond PodcastThe World of Goldeneye mit Nicolás Suszczyk (Interview auf englisch)Bevor das 25-jährige Jubiläum von Goldeneye endet, sprechen Kai und Sebastian mit dem wahrscheinlich größten Fan des Film, den die Welt je gesehen hat. Nicolás Suszczyk ist aber nicht nur ein Goldeneye-Ultra, sondern auch noch der Autor von „The World of Goldeneye“. Zusammen sprechen Sie über das Buch, einen argentinischen Bond-Ripoff und die Zukunft von 007. Außerdem gibt es die Bond-News und etwas zu gewinnen.
Bitte beachten: Das Interview ist auf englisch. Der Anfang und das Ende der Folge sind auf deutsch.
Mail: podcast-007@outlook.de
Twitter: @007_Podcast_DE
Facebook: @007PodcastDE
Instagram: instragram.com/007_podcas...
2020-11-192h 06
Die Skorpion und Batterie Show | Die On-Demand Late-Night-Show aus Berlin!Die Skorbut und Diphtherie Show – Folge 03: Schimpfworte, Entspannung und der Cyborg-AuflaufDie neue Folge beginnt mit Trommelfeuer aus der Dünnschiss-Haubitze – Das ist nämlich nur eins der vielen Schimpfworte, die sich Commodore Schmidlabb für diese Sendung ausdenken musste. Der American Cyborg Terminator 2000 verrät uns im Gegenzug, ob er nun das Power-Napping erlernt hat und was in seinen legendären Cyborg-Auflauf kommt. Außerdem gibt es neue Musik- und Videotipps und Mitmach-Aufgaben für Literaten.
Feedback an:
Mail: subs-podcast@hotmail.com
Twitter: @PodcastSubs
Website: mdavs.de
Mailbox unter: 030 - 20 84 86 83
2020-11-1826 min
Die Skorpion und Batterie Show | Die On-Demand Late-Night-Show aus Berlin!Die Skorbut und Diphtherie Show – Folge 02: Duke Nukem vs. Klaus und KlausDiesmal lösen die Jungs auf, wie sich der Klassiker „An der Nordseeküste“ auf japanisch anhören würde und was der Nationalhymne von San Marino zum Klassikerstatus noch fehlt. Außerdem sprechen sie über einen Helden ihrer Jugend. Nein, nicht Frank Zander und auch nicht Ricky Harris… gemeint ist natürlich der Großvater aller Videospiel-Großmäuler: Duke Nukem. Commodore Schmidlabb hat in seinen Krempelkisten gekramt und dort noch etwas Merchandise zum Duke gefunden – Darunter eine CD mit Geheimnissen.
Feedback an:
Mail: subs-podcast@hotmail.com
Twitter: @PodcastSubs
Website: mdavs.de
Mailbox unter: 030 - 20 84 86 83
2020-11-1236 min
Die Skorpion und Batterie Show | Die On-Demand Late-Night-Show aus Berlin!Die Skorbut und Diphtherie Show – Folge 01: Nachbarn, Teufelskerle und englisches FernsehenAb sofort bieten euch Commodore Schmidlabb und der American Cyborg Terminator 2000 im Lockdown light JEDE WOCHE leichte Unterhaltung. In dieser Folge reden die beiden über Arbeitslosigkeit, freundliche Nachbarn und furchtlose Teufelskerle. Außerdem gibt es jede Woche eine Aufgabe zum Mitmachen.
Feedback an:
Mail: subs-podcast@hotmail.com
Twitter: @PodcastSubs
Website: mdavs.de
2020-11-0530 min
Die Skorpion und Batterie Show | Die On-Demand Late-Night-Show aus Berlin!Skorpion am Morgen – Eure Good-Morning-Show!Nachdem seine Late-Night-Show abgesetzt wurde, versucht sich Commodore Schmidlabb als Moderator eines Frühstücksfernsehen-Formats. Doch hat er überhaupt Erfahrung im Umgang mit Society-Ladies und Astrologinnen? Und viel wichtiger – kann ein Mann wie er in einer Welt des Zahnpasta-Lächelns und der ewigen guten Laune bestehen?
Feedback an:
Mail: subs-podcast@hotmail.com
Twitter: @PodcastSubs
Website: mdavs.de
2020-11-0534 min
Im Gehörgang Ihrer Majestät | Der James Bond PodcastSondersendung: Sir Sean Connery 1930 - 2020Bisher verkörperten 6 Männer James Bond. Doch Sir Sean Connery war das Original.
Ohne ihn hätte die Marke Bond nicht den Stellenwert, den sie auch fast 60 Jahre später noch hat. Sein Tod ist ein herber Verlust für alle Fans des britischen Geheimagenten.
Daher widmen wir Sir Sean eine spontane Sondersendung, in der wir über seinen Beitrag zum 007-Franchise und unseren Bezug zum seinem Werk sprechen. Natürlich wollen wir auch unsere Hörer:innen zu Wort kommen lassen und haben daher einige Audionachrichten von euch mit in die Sendung genommen.
Wollt ihr uns noch eine Gesch...
2020-11-0346 min
Im Gehörgang Ihrer Majestät | Der James Bond PodcastThe Goldfinger FilesDiesmal reisen Kai und Sebastian in die Schweiz, um dort Steffen Appel und Peter Wälty – die Autoren des Bildbandes „The Goldfinger Files“ – zu treffen. Das Buch gewährt einen tiefen Einblick in die Dreharbeiten von Sean Connerys dritten Bondfilm und präsentiert der Bond-Community eine Vielzahl von noch nie gesehenen Bildern.
Außerdem berichten die beiden von der Buchpräsentation in Zürich und ihrer Reise an die Drehorte von Goldfinger in Andermatt. Zuletzt gibt es noch ein Rezept für einen tollen, misslungenen Cocktail und die Nachrichten aus der Welt von 007.
Mail: podcast-007@outlook.de
Twitter: @007_Podcast_DE
Facebook: @007P...
2020-10-272h 03
Im Gehörgang Ihrer Majestät | Der James Bond PodcastSolo von William BoydDie Zeit, bis „No Time to Die“ in die Kinos kommt, erscheint euch trotz der Film- und Serientipps aus unserer letzten Sendung immer noch zu lang? Dann haben wir für euch eine James-Bond-Geschichte, die leider nur wenig Beachtung findet: Solo von William Boyd
Mit unserem Gast Björn sprechen wir über den Roman (und das ausgezeichnete Hörbuch, gelesen von Dietmar Wunder), in dem 007 im Alleingang einen Krieg beenden soll. Außerdem sprechen wir über die Verbindung zwischen „Ein Quantum Trost“ zur Trump-Ära und loben mal wieder Timothy Dalton über den grünen Klee.
Da wir das Buch von von s...
2020-09-172h 33
Die Skorpion und Batterie Show | Die On-Demand Late-Night-Show aus Berlin!Sex, Exkremente und Alkohol (mit Data sein Hals & Kompendium des Unbehagens)Jeder Showmaster versucht, seine Erfolge zu wiederholen. Daher versucht auch Commodore Schmidlabb an seine beliebte Sauf-Folge anzuknüpfen. Mit ihm geben sich dieses mal Michael (vom Kompendium des Unbehagens) und Markus (von „Data sein Hals“ und „Der Sumpf“) die Kante.
Heraus kam ein lockeres Gespräch über Seifenopern, japanische Trinkkultur und gerissene Schließmuskel. Obendrein sprechen sie über die Top 5 der Prominenten, bei denen es zu Hause wahrscheinlich aussieht wie in einem Saustall.
Kanpai!
Feedback an:
Mail: subs-podcast@hotmail.com
Twitter: @PodcastSubs
2020-07-301h 29
Im Gehörgang Ihrer Majestät | Der James Bond PodcastThe other Fellas – Was gucken, bis No Time to Die kommt?Da es immer noch eine lange Zeit dauert, bis wir das neue Abenteuer von 007 im Kino bestaunen dürfen, stellen wir euch in dieser Folge einige Bücher, Filme und Serien vor, die euch die Zeit bis „No Time to Die“ verkürzen sollen. Außerdem tauchen wir ein in die Welt der Agenten und beschäftigen uns mit dem Phänomen der Sexspionage. Zuletzt gibt es eine Musik-Empfehlung, die Bond-News und sogar etwas zu gewinnen!
Mail: podcast-007@outlook.de
Twitter: @007_Podcast_DE
Facebook: @007PodcastDE
Instagram: instragram.com/007_podcast_de
Website: mdavs.de
Learn more about your a...
2020-07-281h 54
Im Gehörgang Ihrer Majestät | Der James Bond Podcast25 Jahre Goldeneye (Teil 3) – Das FinaleUnsere Geburtstagsgala zum 25-jährigen Jubiläum von Goldeneye geht in die letzte Runde. Auf dem Weg zum Showdown besprechen wir diesmal die berühmte Panzer-Verfolgungsjagd und lästern über das Bösewicht-Versteck von 006. Zudem würdigen wir die Leistung der Modellbau-Legende Derek Meddings und stellen die ganz wichtigen Fragen: Wer zum Teufel ist Mr. Falcon und warum lässt sich 007 vom Knutschen abhalten?
Mail: podcast-007@outlook.de
Twitter: @007_Podcast_DE
Facebook: @007PodcastDE
Instagram: instragram.com/007_podcast_de
Website: mdavs.de
Learn more about your ad choices. Visit megaphone.fm/adchoices
2020-07-071h 58
Die Skorpion und Batterie Show | Die On-Demand Late-Night-Show aus Berlin!Das große Making-ofIm Rahmen einer Dokumentation über seine Late-Night-Show nimmt Commodore Schmidlabb seine Hörer*innen mit in den Backstage-Bereich. Dort könnt ihr aus erster Hand erfahren, wie (bildlich gesprochen) die Wurst gemacht wird.
Doch er beantwortet auch Fragen, die ihr ihm gestellt habt. So gibt er nicht nur den Blick hinter die Kulissen frei, sondern auch einen Blick hinter seine Stirn. Was euch dort erwartet? Skeletor, Kartoffelchips, ein alles fressendes Loch und… der Sinn des Lebens?
Mit Hörerfragen dabei: u.A. Britt-Marie vom Frankfurter Kranz und Markus von Data sein Hals.
Feedback an:
Mail: subs-podcast@hotmail.com
Twit...
2020-06-1838 min
Im Gehörgang Ihrer Majestät | Der James Bond Podcast25 Jahre Goldeneye (Teil 2) – Monaco, Merchandise und Éric SerraDie Diskussion über den Film führt uns im zweiten Teil unserer Goldeneye-Gala vom Casino Monte Carlo bis nach Sankt Petersburg. Außerdem lassen wir unsere goldenen Augen über seltsame Fanartikel zum Film streifen und beschäftigen uns mit dem umstrittenen Soundtrack von Éric Serra. Zuletzt machen wir euch Monaco als Urlaubsziel schmackhaft und diskutieren über die tänzerische Präsenz von Pierce Brosnan. Klingt gut? Dann fix runterladen!
Mail: podcast-007@outlook.de
Twitter: @007_Podcast_DE
Facebook: @007PodcastDE
Instagram: instragram.com/007_podcast_de
Website: mdavs.de
Learn more about your ad choices. Visit megaphone.fm/adchoices
2020-06-151h 40
Im Gehörgang Ihrer Majestät | Der James Bond Podcast25 Jahre Goldeneye (Teil 1)Eine neue Zeit – ein neuer Bond! Wir feiern 25 Jahre Goldeneye. Viele 007-Fans bezeichnen das Debüt von Pierce Brosnan als den Beginn einer lebenslangen Liebe. Auch bei uns ist das nicht anders. In Teil 1 blicken wir auf die Entstehung des Drehbuchs und die neuen Gesichter des Franchises – von Martin Campbell bis Daniel Kleinman. Außerdem gibt es News aus der Welt von James Bond und wir absolvieren die Bond-Challenge.
Mail: podcast-007@outlook.de
Twitter: @007_Podcast_DE
Facebook: @007PodcastDE
Instagram: instragram.com/007_podcast_de
Website: mdavs.de
Learn more about your ad choices. Visit megaphone.fm/adchoices
2020-05-192h 03
Die Skorpion und Batterie Show | Die On-Demand Late-Night-Show aus Berlin!Tanz, Rollenspiele und Let's Plays (feat. Mühlenhof Podcast)Diesmal lautet die Mission der Skorpion und Batterie Show Zerstreuung. Daher ballert euch Commodore Schmidlabb eine Vielzahl von Tipps zur Vernichtung der Freizeit um die Ohren. Neben ein paar Videos aus dem Bereich des zeitgenössischen Tanzes, empfiehlt er euch einen Hausbesuch bei Dita von Teese und die anarchistischen Let’s Plays von „Let’s Game it Out“.
Außerdem empfängt der Commodore noch Moritz vom Mühlenhof Podcast, mit dem er in die Welt der Rollenspiele taucht und über Verschwörungsmythen spricht. Ein bunteren Blumenstrauß an Themen würdet ihr in ganz Holland nicht finden!
Die Tipps zur Sendung...
2020-05-1855 min
Die Skorpion und Batterie Show | Die On-Demand Late-Night-Show aus Berlin!Schallplatten, Krimskrams und KarateausweiseWenn während der Coronakrise alle US-Talkmaster ihr Publikum in ihr Zuhause lassen, dann will Commodore Schmidlabb nicht hinterherlaufen. Daher lässt er eine Hörer in sein Allerheiligstes – die Vinylsammlung. Doch auch die Hörer geben Einblick in ihr Privatleben. Sie teilen den Inhalt ihrer Krimskrams-Kisten und heben echte Schätze.
Feedback an:
Mail: subs-podcast@hotmail.com
Twitter: @PodcastSubs
2020-04-221h 09
Die Skorpion und Batterie Show | Die On-Demand Late-Night-Show aus Berlin!Baywatch Nilreb: Staffel 4 - Folge 20: Rettungsschwimmer in Bedrängnis (The Life you Save)Die Skorpion und Batterie Show flüchtet aus der Quarantäne an den Strand von Malibu. Mit Hendrik (vom 90s Podcast, Podsblitz und dem Akte X-Cast) gründet er den fiktiven Baywatch-Podcast "Baywatch Nilreb“. Zusammen besprechen die beiden eine besonders miese Episode der Rettungsschwimmer aus Malibu. Und keine Sorge: Natürlich erklären sie auch, warum ihre Show Baywatch Nilreb heißt.
Feedback an:
Mail: subs-podcast@hotmail.com
Twitter: @PodcastSubs
2020-04-151h 10
Im Gehörgang Ihrer Majestät | Der James Bond PodcastDer James-Bond-Film, den es nie gab.Jahre bevor Pierce Brosnan sein Debüt als 007 gab, liefen die Planungen für einen dritten Auftritt von Timothy Dalton als James Bond. Dieser Film wurde zwar nie gedreht, aber trotzdem beeinflusste er Goldeneye – ja die gesamte Brosnan-Ära – maßgeblich. Kai und Sebastian besprechen daher den Drehbuch-Entwurf von „Bond 17“ und erklären, warum Dalton die Walther PPK an den Nagel hängte.
Mail: podcast-007@outlook.de
Twitter: @007_Podcast_DE
Facebook: @007PodcastDE
Instagram: instragram.com/007_podcast_de
Website: mdavs.de
Learn more about your ad choices. Visit megaphone.fm/adchoices
2020-04-151h 47
Die Skorpion und Batterie Show | Die On-Demand Late-Night-Show aus Berlin!Krimskrams, K-Pop und koreanische KücheDiesmal lässt Commodore Schmidlabb die Hörer in seine Wohnung. Dort öffnet er eine geheimnisvolle Kiste voller Nippes aus der Vergangenheit. Außerdem hat er Thea vom Donna Sori Podcast eingeladen, damit er nicht der Einsamkeit der Quarantäne erliegt. Mit ihr redet er über das Leben in Südkorea. Dabei sprechen sie natürlich nicht nur über die Teilung des Landes. Thea verrät uns auch, zu welcher Musik die Koreaner tanzen, worüber sie lachen und nimmt uns mit in einen koreanischen Supermarkt.
즐겁게 보내세요~
Feedback an:
Mail: subs-podcast@hotmail.com
Twitter: @PodcastSubs
2020-04-071h 09
Im Gehörgang Ihrer Majestät | Der James Bond PodcastKeine Zeit zu sterben, Bond on Bond und der gescheiterte 007 John GavinAuch dieses mal haben wir keine Zeit zu sterben. Dafür gibt es viel zu viele Neuigkeiten über Bond 25 zu besprechen. Zudem blicken wir anhand von Roger Moores Buch „Bond on Bond“ auf die reichhaltige Geschichte von 007 – inklusive des Lebenslaufs eines Mannes, der eigentlich der neue Sean Connery werden sollte: John Gavin.
Mail: podcast-007@outlook.de
Twitter: @007_Podcast_DE
Facebook: @007PodcastDE
Instagram: instragram.com/007_podcast_de
Website: mdavs.de
Learn more about your ad choices. Visit megaphone.fm/adchoices
2020-03-061h 43
Die Skorpion und Batterie Show | Die On-Demand Late-Night-Show aus Berlin!Ein halbnackter Pfirsich, Laser aus dem Hintern und merkwürdige MagazineSeine Geburtstage pflegt Commodore Schmidlabb am liebsten allein zu verbringen, nur gestört von den nervigen Anrufen der Gratulanten. Warum sollte er es in seinem Podcast anders machen? Dementsprechend kehrt er für seine Jubiläumsausgabe zum gewohnten Selbstgesprächs-Format zurück. So redet er in in der Einsamkeit seines Studios über Laserstrahlen aus dem Hintern und seine Leidenschaft zu seltsamen Zeitschriften. Könnte doch ganz vergnüglich werden, wenn nicht zu viele Anrufer den Frieden stören...
Feedback an:
Mail: subs-podcast@hotmail.com
Twitter: @PodcastSubs
2020-02-1237 min
Im Gehörgang Ihrer Majestät | Der James Bond PodcastSecret Cinema: Casino Royale, No time to die und wer ist eigentlich Billie Eilish?Ab sofort berichten Kai und Sebastian über Nachrichten und Hintergründe aus der Welt von 007. In ihrem Debüt erklärt das Duo (das sich stilecht auf dem Piz Gloria aus „Im Geheimdienst Ihrer Majestät“ kennenlernte), was beim „Secret Cinema: Casino Royale“ so los war. Zum Abschluss diskutieren sie die Verpflichtung von Hans Zimmer für „No Time To Die“ und wer eigentlich diese Billy Eilish ist.
Wir danken Q the Music für die Titelmusik.
---------
SPRECHT MIT UNS!
Hier findet ihr alle unsere Links: https://www.wonderlink.de/@podcast007
---------
UNTERSTÜTZT UNS!
Bei Ko...
2020-02-071h 22
Die Skorpion und Batterie Show | Die On-Demand Late-Night-Show aus Berlin!After Dark: Die Skorpion und Alkohol Show: Tipps für Trinker, Sex-Ratgeber und prominente OhrfeigengesichterSchon immer träumte Commodore Schmidlabb davon, eine wichtige Station im Leben eines Talkmasters zu absolvieren: den alkoholisierten Talkgast. Doch da Til Schweiger und Jenny Elvers einen breiten Bogen um die Skorpion und Batterie Show machen, sorgt der olle Schmidlabb einfach selbst für die Druckbetankung seiner Gäste. Herausgekommen ist ein beschwipstes Gespräch über die Top 5 der größten Ohrfeigengesichter und wertvolle Ratschläge für das Schlafzimmer *Zwinker Zwonker*
Feedback an:
Mail: subs-podcast@hotmail.com
Twitter: @PodcastSubs
2020-01-081h 32
Die Skorpion und Batterie Show | Die On-Demand Late-Night-Show aus Berlin!Eine exzentrische Waliserin, ein vorbestrafter König und das kulinarische HamburgCommodore Schmidlabb macht seine Drohung war und spricht erstmals über zeitgenössischen Tanz – ohne davon auch nur den Hauch einer Ahnung zu haben. Anschließend wechselt er in das Fach Musik (von dem er auch keine Ahnung hat) und stellt seine Lieblings-Alben des Jahres 2019 vor. Außerdem vermittelt er nutzloses Halbwissen über einen Fantasiestaat südlich von Berlin und blickt zurück auf eine winterliche Fresstour durch Hamburg.
Feedback an:
Mail: subs-podcast@hotmail.com
Twitter: @PodcastSubs
2019-12-051h 00
Die Skorpion und Batterie Show | Die On-Demand Late-Night-Show aus Berlin!Infomercials, Handy-Games und ein PsychotestWollt ihr den Commodore kennenlernen? …ich meine so richtig kennenlernen? Dann ist diese Folge für euch! Commodore Schmidlabb unterzieht sich einem (leider doch unwissenschaftlichen) Persönlichkeitstest und teilt das Ergebnis mit der Hörerschaft.
Nach diesen tiefen Einblicken wird es so trivial, wie es nur möglich ist. In einer neuen Rubrik spricht er nämlich über seine liebsten Teleshopping-Sendungen und welchen Plastikschrott er schon mal gekauft hat.
Lernen kann man diesmal leider nichts – Stattdessen steuert er das Schiff immer weiter auf den Ozean der Verdummung und stellt seine liebsten Mobile-Games vor.
Feedback an:
Mail: subs-podcast@hotmail.com...
2019-11-0740 min
Die Skorpion und Batterie Show | Die On-Demand Late-Night-Show aus Berlin!Seltsame Pizza, der neue James Bond und italienische GameshowsMit seiner Liebsten spricht der Commodore dieses mal über ihren Trip nach Süditalien. Dort besuchten sie nicht nur das schöne Bari, sondern auch das Weltkulturerbe Matera. Die Felsenstadt spielt nämlich eine wichtige Rolle im nächsten Bond-Film „Keine Zeit zu sterben“. Logisch, dass der Commodore sich das als 007-Ultra sich diesen „Set-Besuch“ nicht entgehen lassen konnte. Außerdem sprachen die beiden über das süße Leben, saure Limonade und absurde italienische Gameshows.
Feedback an:
Mail: subs-podcast@hotmail.com
Twitter: @PodcastSubs
2019-10-101h 04
Die Skorpion und Batterie Show | Die On-Demand Late-Night-Show aus Berlin!Bauhaus-Yoga, Strandfeeling und Sex-KommunistenHabt ihr Lust auf einen kleinen Ausflug? Dann drückt schnell auf Play und begleitet den Commodore bei seinem perfekten Sonntag. Sein erster Ausflug fern der Semmelrogge-Studios führt ihn zum Bauhaus-Yoga, ins Café, an den Strand und zum Schluss vor den heimischen Fernseher. Den Soundtrack zum Trip liefern Popmusiker*innen unseres Nachbarlands Frankreich und ein Wurstmusical (Ja, richtig gelesen). Zum Abschluss erfahrt ihr alles über den italiensichen Superhelden Flashman und Sex-Kommunisten aus Wien. Mehr Sommer-Feeling geht doch kaum, oder?
Feedback an:
Mail: subs-podcast@hotmail.com
Twitter: @PodcastSubs
2019-09-0242 min
Die Skorpion und Batterie Show | Die On-Demand Late-Night-Show aus Berlin!Wolfenstein, Mortal Kombat und kunstvolles FurzenAuf Wunsch eines Hörers hebt Commodore Schmidlabb eine neue Rubrik aus der Taufe. Diesmal sucht er sein Gamer-Herz und entdeckt dort Wolfenstein, Mortal Kombat und Super Mario. Damit es auch was zu Lernen gibt, spricht der Commodore auch noch über den französischen Kunstfurzer Joseph Pujol. Mon dieu!
Feedback an:
Mail: subs-podcast@hotmail.com
Twitter: @PodcastSubs
2019-08-1236 min
Die Skorpion und Batterie Show | Die On-Demand Late-Night-Show aus Berlin!Wut, Boxen und Osaka-HumorDer Briefträger hat zweimal geklingelt. Daher beantwortet Commodore Schmidlabb diesmal etwas Hörerpost und ruft als Reaktion auf die Nachricht eine neue Rubrik ins Leben. Außerdem hat schon wieder ein Gast seinen Weg in die Semmelrogge-Studios gefunden. Michael vom Kompendium des Unbehagens erzählt von seinem Leben in Osaka und erklärt uns den Unterschied zwischen Osaka-Humor und Tokio-Humor. Natürlich besprechen die beiden auch zwei Themen, die dem Commodore am Herzen liegen: Japanisches Essen und Spielshows!
Feedback an:
Mail: subs-podcast@hotmail.com
Twitter: @PodcastSubs
2019-07-0452 min
Die Skorpion und Batterie Show | Die On-Demand Late-Night-Show aus Berlin!London, Weltraumbestattungen und japanische Indie-BandsAlles neu macht der Mai heißt es in einem Volkslied. Das dachte sich auch der Commodore, denn zum ersten mal hat er sich einen Gast eingeladen – so richtig aus Fleisch und Blut und dem ganzen Gedöns. Besagter Gast ist der Kopf des Plattenlabels Get your Genki, das sich zum Ziel gesetzt hat, die verborgenen Schätze der japanischen Indie-Szene ans Licht der Öffentlichkeit zu fördern. Gemeinsam sprechen sie über ägyptische Hüte, schwere Morgenmäntel und natürlich auch über Koks und Nutten.
Feedback an:
Mail: subs-podcast@hotmail.com
Twitter: @PodcastSubs
2019-06-0445 min
Die Skorpion und Batterie Show | Die On-Demand Late-Night-Show aus Berlin!Karl Friedrich Schinkel, Weltraumkolonien und die SimpsonsDiesmal beantwortet Commodore Schmidlabb Fragen aus der Hörerschaft. Es geht um Architektur im Allgemeinen und Karl Friedrich Schinkel im Speziellen. Außerdem quatscht er über die Twilight-Zone, die Simpsons und haut bei der Deutschen Eishockeyliga auf den Tisch. Natürlich gibt es auch wieder unnützes Partywissen und ein musikalisches Bonmot aus dem Hause Schmidlabb.
Feedback an:
Mail: subs-podcast@hotmail.com
Twitter: @PodcastSubs
2019-04-1527 min
Die Skorpion und Batterie Show | Die On-Demand Late-Night-Show aus Berlin!Russisches Radio, koksende Musiker und Hähne auf dem EisCommodore Schmidlabb droppt sein Solo-Album! In der ersten hochoffiziellen Folge der Skorpion und Batterie Show bringt er unnützes Wissen aus der Welt der Geheimdienste unter die Leute, vergeht sich an einem musikalischen Genie und schwärmt von einer eiskalten Leidenschaft.
Feedback an:
Mail: subs-podcast@hotmail.com
Twitter: @PodcastSubs
2019-02-2232 min
Die Skorpion und Batterie Show | Die On-Demand Late-Night-Show aus Berlin!Noch einmal mit Gefühl... (feat. Zimmerlautstärke & Die Rückspultaste)Damit der dritte Geburtstag der Skorpion und Batterie Show nicht der letzte bleibt, klemmt Commodore Schmidlabb jetzt das Starthilfe-Kabel an die tropfende Batterie seines Talk-Show-Vehikels.
So hat er sich vorgenommen, eine neue Folge Nummer 1 aufzunehmen, die so viel interessanten Stoff enthält, das potentielle neue Hörer:innen nicht mehr anders können, als alle Folgen der Show in einem Rutsch zu konsumieren. Um dieses Ziel zu erreichen, hat der Lieblings-Podcaster eurer Mütter alles in die Folge gepackt, was die Sendung ausmacht: alberne Gags, nutzloses Partywissen über die Geschichte des Balletts.
Alle Links und Videos zur F...
2019-02-211h 41
Die Skorpion und Batterie Show | Die On-Demand Late-Night-Show aus Berlin!Sammelfrust, James Bond und Sherlock HolmesIn der Testfolge seiner Solo-Show, die er „Die Skorpion und Batterie Show“ getauft hat, gewährt euch der Commodore einen Einblick in seine Filmsammlung und denkt laut über den nächsten James-Bond-Film nach. Darüber hinaus gibt es ein bisschen Musik, einen kleinen Gastauftritt und ihr werdet auch erfahren, warum zu Kuckuck die Show so heißt, wie sie nunmal heißt.
Feedback an:
Mail: subs-podcast@hotmail.com
Twitter: @PodcastSubs
2019-01-0438 min